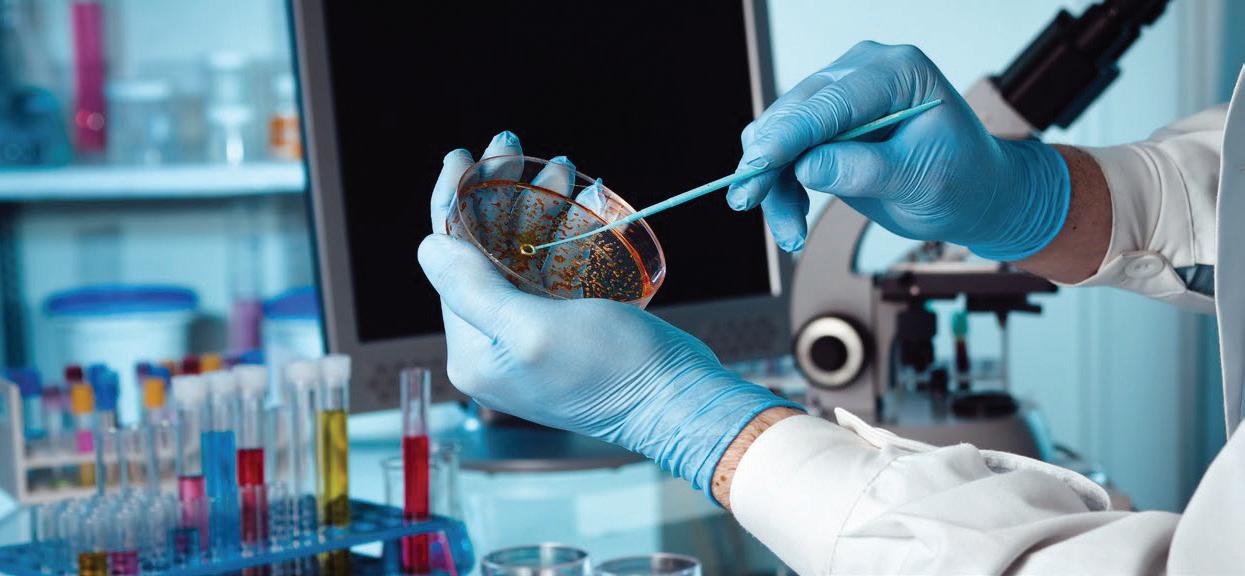

Rabbits Don’t Come Easy Stop INDUSTRIAL CRUELTY ?

Thailand Industry Outlook: MEDICAL DEVICES
National & Global Perspectives on FEED INDUSTRY
MYCOTOXIN Screening Tests

PLANT-BASED SEAFOOD Development
Three Key Changes Affecting the SHELF LIFE of Food Products



www.Ohaus.com Add Friend with our Line ID:@Ohaus OHAUS LAB Weighing Products Portfolio EX5 MB27 MB23 NV CX CR MB120 SPX AX PX PR


846/4 Lasalle Road, Bangna-Tai Sub-district Bangna District, Bangkok, Thailand 10260 Ohaus Indochina LTD. Tel: +662 7196418-19 E-mail: wutti.techakasembundit@ohaus.com natchuda.boonbunlu@ohaus.com OHAUS LAB Equipment Products Portfolio
FC2706 FC2516
Bead Homogenizer FC5816R
Vortex Mixer
Dry Block Heater
Overhead Stirrer G3000 AB41PH AB33M1
Multitube Vortex
Shaker
Bunny Runs!
Rabbits are not only cute pets but they are symbols in several cultures. For examples, Easter of Christian and the fourth year of Chinese zodiac. Moreover, they have been used in scientific area also. They are used for testing the safety of products before launching to the market especially cosmetics. There are a lot of animal used in testing. There are 192.1 tested animals in diversified experiments. Even the anti-cruelty campaign rises, they are needed to be used for human safety.
Safety is for human but not for rabbit.
Karuna Chinthanorm Chief Editorial Officer
SOMKID RUENPARKWOOT somkid-doa@hotmail.com
SUPAWAT SUKMARK ss@media-matter.com
KARUNA CHINTHANOM kc@media-matter.com
ชัฏไพศาล APAPAN CHATPAISARN editor@media-matter.com สิทธิพร ชมภูรัตน์ SITTHIPORN CHOMPURAT journalist@media-matter.com
ศรีสุข BENJAMAS SRISUK innolab@media-matter.com
จีนถนอม WANASANAN CHINTHANOM agency@media-matter.com THU DO innolab.vn@media-matter.com

PUBLISHER
43/308
10150
43/308 Moo 1, Jomthong Road, Jomthong, Bangkok 10150 Thailand TaxID 0105552007301
+66 875171651 F +66 2045 5358 innolab@media-matter.com
http://www.innolabmagazine.com innolabmagazine
The publisher endeavors to collect and include complete, correct and current information in INNOLAB but does not warrant that any or all such information is complete, correct or current. The publisher does not assume, and hereby disclaims, and liability to any person or entity for any loss or damage caused by errors or omissions of any kind, whether resulting from negligence, accident or any other cause. INNOLAB does not verify any claims or other information appearing in any of the advertisements contained in the magazine, and cannot take any responsibility for any losses or other damages incurred by readers in reliance on such content.
4 www.innolabmagazine.com
บริษัท มีเดีย แมทเทอร์ จำ�กัด (สำ�นักง�นใหญ่)
หมู่ 1 ถนนจอมทอง แขวงจอมทอง เขตจอมทอง กรุงเทพฯ
กระต่ายไม่ได้เป็นเพียงสัตว์เลี้ยงที่น่ารักเท่านั้น แต่ถูกใช้เป็น สัญลักษณ์ในหลากหลายวัฒนธรรมอีกด้วย ไม่ว่าจะเป็นเทศกาล อีสเตอร์ เทศกาลสำาคัญของชาวคริสต์ หรือแม้แต่เป็นสัญลักษณ์ ของปีที่ 4 ของรอบปีนักษัตรของจีน ซึ่งคือปีเถาะ และกระต่ายยัง ถูกใช้ในวงการวิทยาศาสตร์อีกด้วย ใช้เพื่อทดสอบความปลอดภัย ของผลิตภัณฑ์ต่างๆ ก่อนถึงมือมนุษย์ โดยเฉพาะอย่างยิ่งเครื่อง สำาอาง และยังมีการใช้สัตว์ทดลองประเภทอื่นๆ
ว่ามีสัตว์ 192.1 ล้านตัวถูกใช้ในการทดลองประเภทต่างๆ แม้จะมี การรณรงค์ให้ลดการใช้สัตว์ทดลอง แต่สัตว์ทดลองเหล่านี้ยังคง จำาเป็นต้องใช้เพื่อความปลอดภัยของมนุษย์ มนุษย์ปลอดภัย แต่กระต่ายไม่
อีก ในปี 2015 พบ
Editor’s Note Table of Content #15.87
TESTING & ANALYSIS RABBITS DON’T COME EASY STOP INDUSTRIAL CRUELTY? 8 MYCOTOXIN SCREENING TESTS FOR ANIMAL FEED 14 THREE KEY CHANGES AFFECTING THE SHELF LIFE OF FOOD PRODUCTS 36 R&D PLANT-BASED SEAFOOD DEVELOPMENT 18 INDUSTRY MOVEMENT NATIONAL AND GLOBAL PERSPECTIVES ON FEED INDUSTRY 21 THAILAND INDUSTRY OUTLOOK 2021-23: MEDICAL DEVICES 28 FEATURES 27 ATTRACTIONS HONG KONG TRADE DEVELOPMENT COUNCIL FACILITATES THE NEW COLLABORATION OF GLOBAL HEALTHCARE WITH HONG KONG INTERNATIONAL MEDICAL AND HEALTHCARE FAIR 40 PROPAK ASIA 2023 CELEBRATES ITS 30TH ANNIVERSARY 44 CPHI SOUTH EAST ASIA 2023 SHOWCASES PHARMACEUTICAL INNOVATIONS 46 FI ASIA THAILAND 2023 LAUNCHES THE FAMED ASIAN’S F&B INNOVATION INDUSTRY EVENT 48 CATCH UP PCHI 2023 CONCLUDES WITH RECORD ATTENDANCE IN GUANGZHOU 49 RECORD-BREAKING SUCCESS AT ANALYTICA VIETNAM 2023 52 NEWS 56 ADVERTISERS OHAUS Indochina IFC Thailand LAB on Tour 5 ProPak Asia 6 CPHI South East Asia 7 ASEAN Sustainble Energy Week 27 Carbon Neutrality BC ADVISORY BOARD ปราโมทย์ ธรรมรัตน์ PRAMOTE TAMMARATE ifrpmt@yahoo.com สมคิด รื่นภาควุฒิ
TEAMWORK ศุภวัชร์ สุขมาก
กรุณา จีนถนอม
อาภาพรรณ
วนัสนันท์
กรุณา จีนถนอม หัวหน้าบรรณาธิการ
:: Mar-Apr 2023
เบญจมาศ




ProPakAsia.com For more information @ProPakAsia Edition The 30th International Processing and Packaging Exhibition for Asia 14-17 JUNE 2023 BITEC I Bangkok, Thailand Event is powered by: Organised by: Event Sustainability Standard:


Rabbits Don’t Come Easy

Stop Industrial Cruelty?
การทดลองในสัตว์
หมายถึง ขั้นตอนการทดลองที่ใช้สัตว์ที่มีชีวิตเพื่อวัตถุประสงค์ในการวิจัยเกี่ยวกับชีววิทยาพื้นฐานและโรค การประเมินประสิทธิภาพของเภสัชภัณฑ์ชนิดใหม่
ขั้นตอนทั้งหมดแม้จะจัดอยู่ในกลุ่มไม่รุนแรงก็สามารถทำาให้สัตว์มีความเจ็บปวดทั้ง ทางร่างกายและจิตใจได้ และบ่อยครั้งที่กระบวนการเหล่านี้อาจทำาให้สัตว์ทรมานอย่างมาก
เชื่อว่าสัตว์มีการตอบสนองเช่นเดียวกับมนุษย์เมื่อ สัมผัสกับสารบางชนิด ในปัจจุบัน การทดสอบ เครื่องสำาอางและผลิตภัณฑ์ดูแลร่างกาย และ ผลิตภัณฑ์ในครัวเรือนส่วนใหญ่ มักจะทดสอบ ในระดับส่วนผสมไม่ใช่ผลิตภัณฑ์สำาเร็จรูป ประเภทของสัตว์ทดลอง สัตว์ทดลองทั่วโลกมีสายพันธุ์ต่างๆ
ในแต่ละปี ประมาณการว่ามีสัตว์มากกว่า 115 ล้านตัวถูกใช้ในการทดลองในห้องปฏิบัติ การ แต่เนื่องจากมีเพียงไม่กี่ประเทศที่มีการ รวบรวมและเผยแพร่ข้อมูลเกี่ยวกับการใช้สัตว์ เพื่อการทดลองและการวิจัย จึงไม่ทราบจำานวน ที่แน่นอน ตัวอย่างเช่น ในสหรัฐอเมริกา สัตว์ ที่ใช้ในห้องปฏิบัติการ (หนูที่ผสมพันธุ์เป็น พิเศษ หนูและนก ปลา สัตว์สะเทินน้ำาสะเทิน บก สัตว์เลื้อยคลาน และสัตว์ไม่มีกระดูกสัน หลัง) มากถึง 90% ไม่ได้รวมอยู่ในสถิติอย่าง เป็นทางการ นั่นหมายความว่าตัวเลขที่เผยแพร่ โดยกระทรวงเกษตรแห่งสหรัฐอเมริกาจะต่ำา กว่าความเป็นจริงมากอย่างแน่นอน แต่ละปี สหภาพยุโรปใช้สัตว์มากกว่า 12 ล้านตัว ฝรั่งเศส เยอรมนี และสหราชอาณาจักร เป็นประเทศที่ใช้สัตว์มากที่สุดสามอันดับแรก สถิติจากประเทศอังกฤษแสดงว่ามีการใช้สัตว์ มากกว่า 3 ล้านตัวต่อปี ซึ่งยังไม่รวมถึงสัตว์ที่ เพาะพันธุ์เพื่อการวิจัยแต่ถูกฆ่าเพราะเป็นส่วน เกิน ไม่ได้ถูกนำามาใช้ในการทดลอง ประเภทของการทดสอบ
และการทดสอบสุขภาพของมนุษย์และ/หรือความปลอดภัยต่อสิ่งแวดล้อม ของสินค้าอุปโภคบริโภคและผลิตภัณฑ์สำาหรับอุตสาหกรรม เช่น เครื่องสำาอาง น้ำายาทำาความสะอาดในครัวเรือน วัตถุเจือปน อาหาร ยา และเคมีอุตสาหกรรม/เคมีเกษตร
สัตว์ทดลองส่วนใหญ่จะถูกฆ่าเมื่อสิ้น สุดการทดลอง แต่ก็มีสัตว์บางส่วนที่นำามาใช้ซ้ำาในการทดลองครั้งต่อไป TESTING & ANALYSIS การทดสอบผลิตภัณฑ์ในสัตว์มาจากความ
มากมาย แต่ใช้มากที่สุด ได้แก่ หนู Mice ปลา หนู Rat กระต่าย หนูตะเภา หนูแฮมสเตอร์ ปศุสัตว์ นก แมว สุนัข หมูแคระ และไพรเมตที่ไม่ใช่ มนุษย์
(ลิง และลิงชิมแปนซีในบางประเทศ)
The term ‘animal testing’ refers to procedures performed on living animals for purposes of research into basic biology and diseases, assessing the effectiveness of new medicinal products, and testing the human health and/or environmental safety of consumer and industry products such as cosmetics, household cleaners, food additives, pharmaceuticals and industrial/agro-chemicals. All procedures, even those classified as mild, have the potential to cause the animals physical as well as psychological distress and suffering. Often the procedures can cause a great deal of suffering. Most animals are killed at the end of an experiment, but some may be re-used in subsequent experiments.

Product testing on animals was born from the belief that animals respond the same way that humans do when expose to certain substances. Most animal tests on cosmetics and personal care and household products today are conducted at the ingredient level, not on finished products.

Types of Animals
Many different species are used around the world, but the most common include mice, fish, rats, rabbits, guinea pigs, hamsters, farm animals, birds, cats, dogs, mini-pigs, and non-human primates (monkeys, and in some countries, chimpanzees).
It is estimated that more than 115 million animals worldwide are used in laboratory experiments every year.
But because only a small proportion of countries collect and publish data concerning animal use for testing and research, the precise number is unknown. For example, in the United States, up to 90 % of the animals used in laboratories (purpose-bred rats, mice and birds, fish, amphibians, reptiles and invertebrates) are excluded from the official statistics, meaning that figures published by the U.S. Department of Agriculture are no doubt a substantial underestimate. Within the European Union, more than 12 million animals are used each year, with France, Germany and the United Kingdom being the top three animal using countries. British statistics reflect the use of more than 3 million animals each year, but this number does not include
10 www.innolabmagazine.com
animals bred for research but killed as surplus without being used for specific experimental procedures.
Types of Tests Draize test
The most notorious of animal tests, the Draize eye test was developed in 1944 to assess eye irritation. A substance is placed in one eye of a rabbit, with the other eye serving as a control. The rabbits are restrained, preventing them from responding naturally to the irritation, and their eyes are evaluated at regular intervals up to 14 days. They can suffer from redness, bleeding, ulcers, and even blindness, and are likely killed upon completion of the experiment.

Acute toxicity testing
Acute toxicity testing is used to determine the danger of exposure to a chemical by mouth, skin, or inhalation. An older version of the test, the Lethal Dose 50 (LD50) involved poisoning large numbers of animals until at least half of them die. The fixed dose
method, which does not use death as an endpoint, focuses instead on signs of ailments or suffering. During these tests, animals may endure excruciating pain, convulsions, loss of motor function, and/or uncontrollable seizures. The animals are killed at the end of the test so they can be studied. Rats and mice are the animals most often used in acute toxicity testing.
Skin irritation testing
Skin irritation tests assess the potential of a substance to cause damage to the skin, including itching, swelling, and inflammation. The test most often uses rabbits and involves placing a chemical on a shaved patch of skin and using another shaved patch as a control.
Ecotoxicity testing
Ecotoxicity tests are used to analyze potential negative effects of chemicals entering the environment. The standard acute toxicity test, the LC50 (lethal concentration 50%),
uses fish as a subject and measures the concentration of a chemical that kills 50% of the test population in a 96-hour period. Chronic fish tests last from 7 to more than 200 days and the fish are evaluated for growth, hatching and spawning success, and mortality.
Carcinogencity tests
A carcinogen is a substance or mixture of substances that causes cancer or increases the incidences of cancer. In this test, a chemical is administered orally, placed on the skin, or inhaled over a prolonged duration to mice or rats. After the study is completed, the animals are killed, and their tissues and organs are examined for evidence of cancer.
Reproductive and developmental toxicity
Reproductive toxicity tests measure the toxic effects of a substance on the reproductive ability of an animal, usually a rat or mice, and the toxic effects on the development of its offspring. Developmental toxicity testing involves
giving pregnant female animals, usually rats and rabbits, doses of chemicals administered orally. The animals are killed just prior to delivery and the fetuses are examined for any sign of toxic effects by the test substance.
What’s Wrong with Animal Testing?
For nearly a century, drug and chemical safety assessments have been based on laboratory testing involving rodents, rabbits, dogs, and other animals. Aside from the ethical issues they pose—inflicting both physical pain as well as psychological distress and


suffering on large numbers of sentient creatures—animal tests are time- and resource-intensive, restrictive in the number of substances that can be tested, provide little understanding of how chemicals behave in the body, and in many cases do not correctly predict real-world human reactions.
Trying to mirror human diseases or toxicity by artificially creating symptoms in mice, dogs or monkeys has major scientific limitations that cannot be overcome. Very often the symptoms and responses to potential treatments seen in other species are
dissimilar to those of human patients. Consequently, 9 out of every 10 candidate medicines that appear safe and effective in animal studies fail when given to humans. Drug failures and research that never delivers because of irrelevant animal models not only delay medical progress, but also waste resources and risk the health and safety of volunteers in clinical trials.
What’s the Alternative?
If lack of human relevance is the fatal flaw of animal models, then a
า หนดระบบการ ตรวจสอบอย่างต่อเนื่องเพื่อให้มั่นใจ ว่าซัพพลายเออร์และผู้ผลิตทั้งหมด ของพวกเขาปฏิบัติตามหลักเกณฑ์ของ Leaping Bunny ผลิตภัณฑ์ วัตถุดิบ และส่วนผสมทั้งหมดจะต้องตรวจสอบ ว่าไม่มีการทดลองในสัตว์ใหม่ๆ
จำากัดในการทดลองในสัตว์:
- พวกเขาต้องกำ า หนดวันที่สิ้น สุดที่แน่นอนเป็นกำ า หนดที่ไม่สามารถ
12 www.innolabmagazine.com Leaping Bunny: การรับรองการ ปราศจากการทารุณกรรมต่อสัตว์ Leaping Bunny เป็นการรับรอง ผลิตภัณฑ์ว่าปราศจากการทดลอง ในสัตว์ บริษัทต่างๆ มากกว่า 700 แห่งทั่วโลกได้รับการรับรอง Leaping Bunny เป็นทางเลือกสำาหรับผู้บริโภค ที่มีจริยธรรมที่ต้องการจำาแนกและซื้อ ผลิตภัณฑ์ที่ปราศจากการทดลองใน สัตว์ โลโก้ Leaping Bunny จะออกให้ แก่บริษัทที่ผลิตเครื่องสำาอาง ผลิตภัณฑ์ ดูแลร่างกาย ผลิตภัณฑ์สำาหรับใช้ในครัว เรือน และผลิตภัณฑ์ทำาความสะอาด หลักเกณฑ์ของมาตรฐาน Leaping Bunny เพื่อให้ได้รับการอนุมัติจาก Leaping Bunny แบรนด์ต่าง ๆ จะต้องผ่านเกณฑ์ ที่เข้มงวดซึ่งไม่ใช่แค่การปฏิบัติตามข้อ
เปลี่ยนแปลงได้
หรือซัพพลายเออร์ และผู้ผลิตรายใด ๆ ไม่สามารถดำาเนินการ
หรือ เข้าร่วมในการทดสองในสัตว์ ไม่ว่าจะเป็น วัตถุดิบหรือส่วนผสม ไม่ว่าจะเป็นที่ใดใน โลก* โดยใช้กับห่วงโซ่อุปทานทั้งหมด ไปจนถึงผู้ผลิตส่วนผสมของพวกเขา - พวกเขาไม่สามารถทำาการทดสอบ ผลิตภัณฑ์สุดท้ายไม่ว่าจะเป็นที่ใดในโลก
- พวกเขาต้องกำ
อย่าง น้อยทุก 12 เดือน - พวกเขาต้องจัดให้มีระบบตรวจสอบ ของตนเองเพื่อรับการตรวจประเมินจาก ผู้ตรวจประเมินอิสระเป็นประจำา (ไม่ได้อยู่ ภายใต้ Cruelty Free International) เพื่อตรวจสอบว่าพวกเขายังคงปฏิบัติ เช่นเดิมนับตั้งแต่วันที่สิ้นสุดแน่นอนของ เครื่องสำาอางทั้งหมดของพวกเขา รวม ถึงเครื่องสำาอางชนิดใหม่ทุกชนิดด้วย - แบรนด์ที่ได้รับโลโก้ Leaping Bunny ทั้งหมดต้องปฏิบัติตามหลักเกณฑ์เหล่า นี้ ใช้กับสำาหรับแบรนด์ (เครื่องสำาอาง) ทั้งหมดของตน และใช้ในทุกประเทศ วางจำาหน่าย *เว้นแต่ในกรณีพิเศษที่หน่วยงาน กำากับดูแลกำาหนดให้มีการทดสอบส่วน ผสมที่กำ า หนดไว้แล้วในตลาดสำ า หรับ เครื่องสำ า อางหรือผลิตภัณฑ์ในครัว เรือนซึ่งจำาเป็นต้องมีการทดสอบนั้น และการทดสอบนั้นไม่ ได้มีวัตถุประสงค์เพื่อ ใช้ในเครื่องสำาอางหรือ ผลิตภัณฑ์สำาหรับใช้ใน ครัวเรือน และแบรนด์ ไม่มีการควบคุมโดยสิ้นเชิง ภายใต้การ ประเมินอย่างเป็นทางการในการทดลอง ในสัตว์ทุกครั้งเพื่อให้แน่ใจว่าไม่มีการ ละเมิดหลักเกณฑ์ Leaping Bunny
หลังจากนั้น แบรนด์
มอบหมาย
หลังจากวันที่สิ้นสุดที่แน่นอน
switch to human-relevant research tools is the logical solution. The National Research Council in the United States has expressed its vision of a not-so-distant future in which virtually all routine toxicity testing would be conducted in human cells or cell lines, and science leaders around the world have echoed this view.
The sequencing of the human genome and birth of functional genomics, the explosive growth of computer power and computational biology, and high-speed robot
automation of cell-based (in vitro) screening systems, to name a few, has sparked a quiet revolution in biology. Together, these innovations have produced new tools and ways of thinking that can help uncover exactly how chemicals and drugs disrupt normal processes in the human body at the level of cells and molecules. From there, scientists can use computers to interpret and integrate this information with data from human and population-level studies. The resulting predictions
The Leaping Bunny: Cruelty-Free Certification
regarding human safety and risk are potentially more relevant to people in the real world than animal tests.
Modern non-animal techniques are already reducing and superseding experiments on animals, and in European Union, the 3Rs principle of replacement, reduction, and refinement of animal experiments is a legal requirement. In most other parts of the world there is currently no such legal imperative, leaving scientists free to use animals even where non-animal approaches are available.
The Leaping Bunny is a cruelty free certification for non-animal tested products. More than 700 companies across the globe already hold Leaping Bunny certification, providing a choice for ethical consumers who want to identify and buy products that are free from animal testing. The Leaping Bunny logo is issued for use by companies which produce cosmetics, personal care, household, and cleaning products.
Leaping Bunny criteria
In order to become Leaping Bunny approved, brands must meet rigorous criteria that go beyond compliance with animal testing restrictions:
- They must apply a fixed cut-off date, an immovable date after which neither the brand nor any of its suppliers and manufacturers may conduct, commission or be party to animal tests for raw materials or ingredients anywhere in the world.* This applies for their entire supply chain down to ingredient manufacturer.
- They cannot have had any final product testing anywhere in the world after their fixed cut-off date.
- They must set up a continuous monitoring system to ensure all their suppliers and manufacturers comply with Leaping Bunny criteria and all products, raw materials and ingredients are checked for any new animal testing at least every 12 months.
- They must open their monitoring system to regular independent audits (outside of Cruelty Free International) to check they continue to comply with their fixed cut-off date for all their cosmetics, including any new ones.
- All Leaping Bunny brands must meet these criteria for their entire own brand (cosmetics) and for every country they sell in.
*Unless in the exceptional case that a regulatory agency demands a test for an ingredient already established on the market for cosmetics or household products use where that test is required, and when that test is not for cosmetic or household product purposes, and over which a brand has absolutely no control. Subject to a formal assessment for every incidence of animal testing to ensure no breach of Leaping Bunny criteria.
Article info
Humane Society International (2023, April 20). About Animal Testing. About us: News & Media. Humane Society International. https://www.hsi.org/news-media/about/
Leaping Bunny Program (2023, April 20). Types of Animal Tests. Leaping Bunny Program. https://www.leapingbunny.org/types-animal-tests
ProCon.org (2023, April 23). Should Animals Be Used for Scientific or Commercial Testing? ProCon/Encyclopaedia Britannica. Last updated on March 18, 2020. https://animal-testing.procon.org
13 Mar-Apr
Feed is described as any substance or product, including additives, processed, semi-processed or unprocessed, intended to be used for the feeding of animals. Mycotoxins are among the most important safety risk factors in the feed industry and the safety of the feed supply chain. Cereal grains, which amount to 50–70% of feed weight, are the main sources of mycotoxins, because they are key substrates for mycotoxin-producing fungal growth. Mycotoxins are low molecular weight secondary metabolites produced by filamentous fungi that exert adverse effects at low concentrations in both humans and animals. The most susceptible crops are wheat, maize, barley, oat and rye.
Approximately 300 to 400 mycotoxins have been identified and reported so far. However, regarding their prevalence in feeds and their known effects on livestock health, only a few groups of mycotoxins are considered to be a safety and economic concern, namely, aflatoxins (AFs), fumonisins (FMs), ochratoxins (OTs), trichothecenes (TRCs), and zearalenone (ZEN).
How mycotoxins get into feed?
Various factors are known to influence the incidence of mycotoxins, despite their unavoidable and unpredictable nature. Their production can start in the field throughout the crop growing cycle and continue during harvesting, drying, processing, and storage steps, strongly depending on various environmental conditions. These comprehend not only climatic factors, such as temperature and moisture content which are the main aspects modulating fungal growth and mycotoxins production, but also pH, bioavailability of micronutrients, and insect damage, for example. Others factors like geographic location, agricultural practices, harvest year, and the length and conditions of storage affect the extent of the contamination of a particular commodity. Mycotoxins can appear in the feed chain because of fungal infection of crops, and due to the use of moldy grains and forage as components of animal feed. Moreover, due to the climate changes across the globe, some changes in
the distribution and cycles of the molds are expected, since every mold species has its own optimum conditions of temperature and water activity for growth and formation of toxic metabolites.
Screening Methods for detection of mycotoxins in feed
Usually, screening assays are developed in the form of kits which are extremely relevant tools for monitoring mycotoxin in feed ingredients and feed either by analysts with time constraints for making decisions or by those where other methods may not be available due to cost or situation. These methods for single or whole mycotoxin classes compromise both qualitative tests that show the presence or absence of the target impurity and tests that yield semi-quantitative or quantitative results. Immunoassaybased methods and biosensors are among the screening methods.
Immunoassay-Based Methods
Methods based on immunoassays are settled in the recognition of specific antibodies with mycotoxins that act like antigens. Detection is typically facilitated by the presence of a marker. This compound can be radioactive, chromogenic, or fluorescent and reacts with an enzyme, generally horseradish peroxidase (HRP).
Immunoassays without the marker are based on the natural fluorescence of some mycotoxins, or in measures of conductivity. These tests are
preferably employed for the first level screening and survey studies on mycotoxin contamination due to their simplicity, cheapness, sensitivity, and selectivity, although crossreactivity with structural analogues can occur. Plus, they do not require sophisticated equipment or skilled personnel. These methods are in continuous development in various formats, aiming to provide rapid, portable and easy to operate systems. Enzyme-linked immunosorbent assay (ELISA), lateral flow immunoassay (LFIA). and fluorescence polarization immunoassay (FPIA) are included in this category of screening methods.
LFIA
Lateral flow immunoassay (LFIA) or membrane-based test strips are commercially available in the form of kits providing mainly visual qualitative results that indicate the presence or absence of a specific mycotoxin below a predetermined fixed level. More recently, semi-quantitative detection is possible using a portable photometric strip reader. In LFIA, the sample flows along the strip by capillary migration and two lines are formed, the test line whose intensity is inversely correlated to the mycotoxin concentration, and the control line that allows the assay validation. Therefore, as the concentration of toxin in the sample increases, the test line density decreases. These line densities are converted into quantitative results displayed in
16 www.innolabmagazine.com
ppb or ppm. This is an inexpensive screening tool that enables rapid, one-step, and in situ analysis.
ELISA
Enzyme-linked immunosorbent assay (ELISA) methods represent a commonly used immunoassay method to rapidly monitor mycotoxins and are routinely used by agrofood laboratories. For all regulated mycotoxins, there are commercially available ELISA microtiter plate kits that have well-defined applicability, analytical range, and validation criteria. There are several ELISA formats commonly accessible, however, in this field of analysis the predominant form is the competitive one. This is a strategy normally used when the antigen is small and has only one antibody binding site (epitope), which is the case of mycotoxins. A direct competitive ELISA in a microwell format, which allows the user to obtain exact concentrations in parts per billion (ppb). Free mycotoxin in the samples and controls is allowed to compete with enzyme-labeled mycotoxin (conjugate) for the antibody binding sites. After a wash step, substrate is added, which reacts with the bound conjugate to produce color. More color density means less mycotoxin. The test is read in a microwell reader to yield optical densities. The optical densities of the controls form the standard curve, and the sample optical densities are plotted against the curve to calculate the exact concentration of mycotoxin.
FPIA
Fluorescence polarization immunoassay (FPIA) indirectly measures the rate of rotation of a fluorophore (tracer) in solution based on the competition between the free
mycotoxin on the sample and the mycotoxin labelled with the tracer towards a specific antibody. When tracers bind to the antibodies their rotation is restricted, and consequently, the fluorescence polarization value increases. Therefore, if a sample has a high concentration in the target mycotoxin it competes with the tracer for the interaction with the antibody resulting in free tracers with a faster motion, in other words, a low fluorescence polarization signal. Basically, this value is inversely proportional to the amount of free mycotoxin in the sample. The FPIA is reliable, rapid, easy to perform, and relatively suitable for automation, however, their solution-based nature makes it less easy to use in field scenarios.
Mycotoxin kit selection tips
Technology improvements have allowed testing to be taken out of the traditional laboratory setting and placed in the hands of all operators having minimal laboratory experience.
When choosing a test kit, make sure it meets the demands of the facility. Facilities need to do a risk assessment to determine which grains and feeds need mycotoxin testing. Features such as workflow, extraction solvent, range of results needed, and kit storage can vary kit to kit.
Accuracy - Inaccurate results defeat the purpose of testing.
Speed - Large facilities need to process many samples
Simple test instructions - Having easy to follow instructions is critical to ensure new users are performing the test correctly and obtaining high quality results
Data management capabilities - Mycotoxin kit suppliers should help their customers access their test data in real-time. This helps them make better risk management and merchandising decisions.
User friendliness - Mycotoxin tests should be user-friendly for any employee to perform the test, reducing potential errors from the measurement.

Plant-based Seafood Development

Author info
Wantida Sopiskhaunkhan, Technical Manager, Jebsen & Jessen Ingredients (T) wantida_s@jjsea.com +66 2 787 8767

และคุณค่าทางโภชนาการ กรุณาอ่านต่อ เพื่อรับข้อมูลเชิงลึกอันมีค่าเกี่ยวกับการได้ มาซึ่งเนื้อสัมผัสอันเป็นที่ต้องการ แก้ปัญหา ด้านสูตร และตอบสนองความต้องการด้าน ฟังก์ชันการทำางานผ่านโซลูชันแบบองค์รวม ที่ช่วยเร่งความเร็วในการเปิดตัวสู่ตลาด จัดการกับความท้าทายด้านเนื้อสัมผัส และโปรตีนเพื่อสร้างประสบการณ์การ รับประทานผลิตภัณฑ์จากพืชอันรื่นรมย์ เนื้อสัมผัสเป็นข้อพิจารณาที่สำาคัญอย่าง ยิ่งในการวิจัยและพัฒนาผลิตภัณฑ์อาหาร ทะเลจากพืช
ใจกับเนื้อเทียมแบบเดิมที่มีเนื้อสัมผัสไม่ดี เมื่อกัดเนื้อสัตว์หรืออาหารทะเลที่ทำาจาก พืชจะพบว่าเนื้อสัมผัสสามารถเป็นตัวชี้วัดได้ เลยว่าผลิตภัณฑ์ใดจะชนะเลิศ มันสามารถ เลียนแบบความฉ่ำาของมีทบอลหรือความนุ่ม และความกรุบกรอบของปลาหมึกชุบเกล็ด ขนมปังได้หรือไม่? การสร้างสูตรผลิตภัณฑ์ ที่มาจากพืชอาจมีความซับซ้อน โดยเฉพาะ อย่างยิ่งเมื่อผู้บริโภคต้องการประสบการณ์ การรับประทานที่รื่นรมย์ซึ่งสามารถเลียนแบบ เนื้อสัมผัสของเนื้อสัตว์และอาหารทะเลของ จริง อาหารทะเลจากพืชที่มีเนื้อสัมผัสที่ทำความท้าทายในการสร้างสูตรเนื้อและ
18 www.innolabmagazine.com
นอกจากผลิตภัณฑ์เนื้อสัตว์จากพืชแล้ว อาหารทะเลจากพืชยังเป็นอีกทางเลือกหนึ่ง ที่น่าสนใจ เป็นทางเลือกอื่นนอกเหนือจาก เนื้อสัตว์และผลิตภัณฑ์นมจากพืช การเปิด ตัวผลิตภัณฑ์ใหม่ทั่วโลกสำาหรับอาหารทะเล จากพืชมีอัตราการเติบโตต่อปีแบบทบต้น 30.5%2 ซึ่งสูงกว่าเนื้อสัตว์ทางเลือก
สนใจมากขึ้น พฤติกรรมการซื้อของผู้บริโภค อาหารจากพืชไม่ใช่เรื่องใหม่ในเอเชียตะวันออกเฉียงใต้ เพราะผู้คนคุ้นเคยกับเต้าหู้ เทมเป้ และเนื้อเทียมมานานแล้ว
รวดเร็วในช่วง 4-5 ปีที่ผ่านมา เนื่องจากมนุษย์มีความกังวลเกี่ยวกับผลกระทบของการ บริโภคเนื้อสัตว์ต่อสุขภาพและสิ่งแวดล้อมมากขึ้น โดยพบว่าผู้บริโภคในเอเชียแปซิฟิก 37% ซื้อผลิตภัณฑ์โปรตีนจากพืชในบรรจุภัณฑ์เพิ่มมากขึ้น1 ที่เพิ่มขึ้นและแนวโน้มการเปิดตัวผลิตภัณฑ์ ใหม่จากพืชแสดงให้เห็นถึงการเติบโตอย่าง รวดเร็ว ถือเป็นโอกาสที่ดีสำาหรับผู้ผลิตเนื้อ สัตว์และอาหารทะเลจากพืช การใช้ประโยชน์จากโอกาสที่ยิ่งใหญ่อาจ นำามาซึ่งความท้าทายใหม่ๆ ยกตัวอย่างเช่น ผู้บริโภคไม่พอใจกับทางเลือกจากพืชที่มีอยู่ ในปัจจุบันในแง่ของเนื้อสัมผัสและคุณค่า ทางโภชนาการ3 จากการศึกษาล่าสุดพบว่า ผู้บริโภค 32% และเนื้อสัมผัสของผลิตภัณฑ์แสดงความกังวลต่อรสชาติ ขณะที่ 33% แสดงความกังวลต่อคุณภาพของส่วนผสม
าให้เชื่อ
พึงพอใจนั้นต้องการความสมดุลที่ประณีต
ยิ่งไป
กว่านั้น ความยั่งยืนเป็นสิ่งที่ผู้บริโภคให้ความ
การบริโภคอาหารจากพืชเพิ่มขึ้นอย่างต่อเนื่องและเพิ่มขึ้นอย่าง
เนื่องจากผู้บริโภคไม่ประทับ
และมอบประสบการณ์การรับประทานที่น่า
รรธิดา โสภิสเขื่อนขันธ์
R&D
กำ า หนดสูตรและความเข้าใจปฏิสัมพันธ์ ระหว่างส่วนผสมอย่างเช่นการใช้โปรตีน กับแป้งและ/หรือไฮโดรคอลลอยด์ อาหาร ทะเลทางเลือกสามารถให้ความรู้สึกใน ปากและเนื้อสัมผัสที่ถูกต้อง
ประสบการณ์การรับประทานในอดีตที่ไม่ ดีนักด้วยการเลียนแบบเนื้อสัมผัสของเนื้อ
Plant-based foods are not a new thing in South-East Asia, people have been familiar with tofu, tempeh, and mxock meat for a long time. In spite of that, consumption of plant-based foods has been steadily rising and spiked in the last 4-5 years because people are increasingly concerned about the impact of meat consumption on their health and the environment. In Asia Pacific, 37% of consumers have increased their purchases of packaged products containing plant-based proteins1.
Besides plant-based meat products, plant-based seafood is another interesting application of plant-based meat and dairy alternatives. Globally, new product launches for plant-based seafood alternatives have been growing 30.5% CGAR2, outperforming meat alternatives. Moreover, sustainability is a growing concern for consumers. This uptake in consumer purchase behavior and the trend in new plantbased product launches represent a fast-growing category which unlocks great opportunities for plant-based meat & seafood manufacturers.
Harnessing great opportunities can bring about new challenges. For instance, consumers are not satisfied with current plant-based alternatives in terms of texture and nutrition3. According to recent studies, 32% of consumers have

19 Mar-Apr อาหารทะเลทางเลือกที่ดีช่วยลดช่อง
รสชาติ และเนื้อสัมผัสทั้งก่อนและหลังการปรุง เพื่อ ให้บรรลุเป้าหมายนี้จำาเป็นต้องมีส่วนผสม ที่เหมาะสม ด้วยความเชี่ยวชาญด้านการ
ว่างระหว่างอาหารทะเลจริงและอาหารทาง เลือกจากพืชโดยส่งมอบรูปลักษณ์
และปรับปรุง
ค้นหาปฏิสัมพันธ์ระหว่างส่วนผสมที่ เหมาะสมตามวิทยาศาสตร์ส่วนผสมอาหาร อย่างเช่น การทำางานของส่วนผสม ปฏิสัมพันธ์ระหว่างส่วนผสม เช่น การทำางานร่วมกันและการตอบโต้ ทั้งหมดข้างต้นเป็นโซลูชันที่ซับซ้อนตัวแปรเสริมของการแปรรูปอาหาร จำาเป็น ต้องทำาการวิจัย ศึกษา ทดลอง ทดสอบ และวิเคราะห์ ซึ่งถือเป็นความท้าทายใน การวิจัยและพัฒนา ความเข้าใจอย่างลึก ซึ้งเกี่ยวกับเนื้อสัมผัสและการทำางานของ ส่วนผสมเป็นกุญแจสำาคัญในการแก้ปัญหา นี้รวมถึงการเลียนแบบเนื้อสัมผัสของเนื้อ สัตว์และอาหารทะเลของจริง ขณะที่ส่วน ผสมสำ า เร็จอาจหาได้จากซัพพลายเออร์ ด้านส่วนผสมอาหารหลายราย แต่การ ทำางานร่วมกับพันธมิตรโซลูชันที่เหมาะสม จะเป็นประโยชน์ต่อผู้ผลิตในแง่ของการวิจัย และพัฒนา ความร่วมมือนี้สามารถช่วยลด เวลาในการวิจัยและเร่งการเปิดตัวผลิตภัณฑ์ ใหม่ออกสู่ตลาด Culinology® เป็นการผสมผสานระหว่าง ศิลปะการประกอบอาหาร วิทยาศาสตร์การ อาหาร และเทคโนโลยี นำาเสนอโซลูชันที่ ครอบคลุมเพื่อช่วยฝ่ายวิจัยและพัฒนาใน การพัฒนาผลิตภัณฑ์ใหม่ เช่น อาหาร ทะเลทางเลือก ด้วยความเชี่ยวชาญในการ ประยุกต์และความสามารถทางประสาท สัมผัส Culinology® สามารถตอบสนอง ความต้องการของลูกค้า โดยเฉพาะความ ชอบด้านรสชาติและเนื้อสัมผัสของอาหาร ทดแทนเนื้อสัตว์หรืออาหารทะเล ซึ่งแตก ต่างกันอย่างมากในแต่ละประเทศ
สัตว์หรืออาหารทะเลให้เหมือนจริงที่สุด
expressed concerns regarding the taste and texture of products, while 33% have raised concerns about the quality of ingredients and nutritional value. Keep reading for valuable insights on achieving ideal textures, solving formulation challenges, and satisfying functional requirements through holistic solutions that boost speed to market.
Addressing texture and protein challenges to create enjoyable plant-based product eating experiences

Texture is a crucial consideration in the research and development of plant-based seafood products, as consumers have been unimpressed with the poor texture of traditional mock meat. When biting into plantbased meat or seafood, texture can help determine a winning product. Does it mimic the properties of juicy meatballs or the tenderness and crunch
of breaded calamari? Formulating a product in the plant-based space can be complex, especially when consumers demand an enjoyable eating experience that mimics the ideal texture of real meat and seafood. The challenges of creating plant-based meat and seafood formulations with convincing textures and satisfying eating experiences requires an intricate balance.
A good seafood alternative narrows the gap between real seafood and the plant-based alternative by delivering on appearance, taste and texture before and after cooking. To achieve this, the right ingredients are needed. With formulation expertise and understanding ingredient interactions such as use of proteins with starches and/or hydrocolloids, seafood alternatives can achieve both the right mouthfeel and texture and improve the historically poor eating experience by closely mimicking
the texture of real meat or seafood. Finding the right interaction of ingredients is based on food ingredients sciences such as
- Functionality of ingredients
- Ingredients interaction such as synergism and countering action
- Food processing parameters
All above are complex solutions that need to be researched, studied, trial tested and analyzed, posing a challenge to R&D. The in-depth understanding of texture and ingredient functionality is key to solving this challenge and mimicking real meat and seafood textures. While blended ingredients may be sourced from various food ingredient suppliers, working with the right solutions partner can be advantageous for manufacturers in terms of R&D. This partnership can help reduce research time and accelerate the launch of new products in the market.
Culinology® involves the combination of culinary arts, food science, and technology, offering a comprehensive solution to aid R&D in developing new products such as seafood alternatives. With expertise in application and sensory capabilities, Culinology® can cater to customer demands, particularly their preferences for taste and texture in meat or seafood substitutes, which vary significantly across different countries.
Article info
1) 2020 ATLAS Proprietary Consumer Insights Program
2) Innova market insights 2023
3) 2020 Innova Market Insights, Top Ten Trends Survey (Average of India, China and Indonesia data)
20 www.innolabmagazine.com
National and Global Perspectives on Feed Industry

อุตสาหกรรมอาหารสัตว์เป็นอุตสาหกรรมกลางน้ำาที่เป็นตัวเชื่อมต่อระหว่างภาคเกษตรกรรมกับ
2562 - 2565
ในปี 2562 อุตสาหกรรมอาหารสัตว์
2.6 แสนล้านบาท และในช่วง 5 ปีนี้มีการเติบโตสูงถึงร้อยละ
ต่อปี ปี 2562 มีปริมาณการผลิต อาหารสัตว์อยู่ที่ 20.2 ล้านตัน การผลิต อาหารสำาหรับสัตว์ปีกมากที่สุด 11.4 ล้าน ตัน รองลงมาคือ อาหารสุกร 5.5 ล้านตัน อาหารสัตว์น้ำามีปริมาณ 1 ล้านตัน และ อาหารสัตว์เคี้ยวเอื้อง 0.9 ล้านตัน และ ในปี 2563 - 2565 อุตสาหกรรมอาหาร สัตว์มีการขยายตัวเนื่องจากอุปสงค์เนื้อสัตว์ ที่เพิ่มขึ้นอย่างต่อเนื่อง
ว่าในปี 2564 อาหารสำาหรับสัตว์เลี้ยงมีการ ส่งออกเพิ่มขึ้นอย่างต่อเนื่อง ผลิตภัณฑ์ที่ มีการส่งออกมากที่สุด
อาหารกระป๋องสำาหรับสัตว์เลี้ยง และอาหาร เม็ดสำาหรับสัตว์เลี้ยง คิดเป็นสัดส่วน 55% และ 41% ตามลำาดับ
ผลิตอาหารสัตว์ทั่วโลก การระบาดใหญ่ของ โรคโควิด-19 ทั่วโลกมีผลกระทบอย่างยิ่ง ต่อภาคเกษตรและอาหารกลายเป็นความ ท้าทายในห่วงโซ่อุปทาน เป็นตัวเร่งให้มี การใช้เทคโนโลยีใหม่และการดำาเนินการ ตามแนวทางปฏิบัติด้านสิ่งแวดล้อมที่ยั่งยืน จากรายงานผลผลิตโดยน้ำาหนักอาหารสัตว์ จากประเทศต่างๆ เพิ่มขึ้น 2.3% จากปี 2564 ที่มีผลผลิต 1.235 พันล้านเมตริกตัน
เนื่องจากต้นทุนวัตถุดิบอาหารสูง ในขณะ ที่ราคาขายปลีกไข่ไก่ยังเท่าเดิมหรือลดลง ความตระหนักด้านสวัสดิภาพสัตว์ก็เป็น ตัวขับเคลื่อนเช่นกัน ทำาให้มีการเลี้ยงไก่ ไข่แบบไม่ขังกรงและเลี้ยงแบบปล่อยมาก ขึ้นในหลายประเทศ ประเทศในยุโรปที่การ ผลิตลดลงอย่างมีนัยสำาคัญ ได้แก่ นอร์เวย์ รัสเซีย ยูเครน และโปแลนด์ ส่วนการผลิต ในภูมิภาคเอเชียแปซิฟิกก็ลดลงเช่นกัน ใน ขณะที่ผลผลิตในออสเตรเลียเติบโตขึ้น 4% โดยน้ำาหนัก ปัจจัยต่างๆ ได้กระตุ้นธุรกิจไก่เนื้อ ได้แก่ อุปสงค์ในการประกอบอาหารที่บ้าน ในช่วงการระบาดของโรคโควิด-19 เนื่องจาก ร้านอาหารปิดตัวลงระหว่างมีการระบาด นอกจากนั้น เนื้อไก่เป็นตัวเลือกที่ราคาไม่ แพงเมื่อเทียบกับแหล่งโปรตีนอื่นๆ การ ผลิตอาหารไก่ในจีนและอินเดียเพิ่มมากขึ้น ในอัตราที่สูงที่สุดในภูมิภาคเอเชียแปซิฟิก ส่วนภูมิภาคละตินอเมริกามีผลผลิตเพิ่ม ขึ้น 5% โดยมีเปรู บราซิล ปารากวัย และ เม็กซิโกเป็นผู้ผลิตสำาคัญ
อาหารสุกร
อุตสาหกรรมการเลี้ยงสัตว์ อุบัติการณ์ในอุตสาหกรรมอาหารสัตว์ เช่น วัตถุดิบไม่เพียงพอ ขาด เทคโนโลยี ปัญหาด้านคุณภาพและความปลอดภัย ย่อมส่งผลกระทบต่ออุตสาหกรรมปลายน้ำา และ ความมั่นคงทางอาหารในที่สุด INDUSTRY MOVEMENT
ศูนย์วิเคราะห์เศรษฐกิจ ธนาคาร ทหารไทยธนชาต นำาเสนอการวิเคราะห์ อุตสาหกรรมอาหารสัตว์ในปี
ว่า
การผลิตและแนวโน้มอาหารสัตว์ทั่วโลก รายงาน 2022 Alltech Agri-Food Outlook ได้นำาเสนอข้อมูลการสำารวจการ
ประเทศผู้ผลิตอาหารสัตว์สิบอันดับแรกใน ปีที่ผ่านมา ได้แก่ จีน (261.424 ล้านตัน) สหรัฐอเมริกา (231.538 ล้านตัน) บราซิล (80.094
(44.059 ล้าน ตัน) เม็กซิโก (38.857 ล้านตัน) สเปน (35.580 ล้านตัน) รัสเซีย (33.000 ล้าน ตัน) ตุรกี (25.300 ล้านตัน) ญี่ปุ่น (24.797 ล้านตัน) และเยอรมนี (24.506 ล้านตัน) ประเทศที่มีการผลิตอาหารสัตว์เพิ่มขึ้น มากที่สุดโดยน้ำาหนักคือจีน เพิ่มขึ้น 8.9% เป็น 261.424 ล้านตัน แนวโน้มสำาคัญที่ ส่งผลทำาให้มีการเติบโต คือ ความต่อเนื่อง ของการควบรวมกิจการและการปรับปรุง อุตสาหกรรมอาหารสัตว์ของประเทศให้ทัน สมัย ฟาร์มสุกรและการผลิตอาหารสัตว์ได้ เปลี่ยนจากการใช้ประโยชน์จากเศษอาหาร เป็นการทำาข้อตกลงร่วมกับผู้ผลิตอาหาร สัตว์มืออาชีพ ทำาให้ปริมาณอาหารสัตว์เชิง พาณิชย์เพิ่มขึ้น โดยเฉพาะอย่างยิ่งจากการ เติบโตและการปรับปรุงภาคการผลิตสุกรให้ ทันสมัยอย่างต่อเนื่อง อาหารไก่ ภาคการเลี้ยงสัตว์ปีก (ไก่) ลดลงโดย น้ำาหนักที่ 1.4% การผลิตอาหารไก่เนื้อเพิ่ม ขึ้น 2.3% จากปี 2565 ธุรกิจเลี้ยงไก่ไข่ ในหลายประเทศประสบกับความท้าทาย
ของประเทศไทยมีมูลค่า
7-10
กรมปศุสัตว์รายงาน
ได้แก่ ผลิตภัณฑ์
ล้านตัน) อินเดีย
การผลิตอาหารสุกรเพิ่มขึ้นอย่างมีนัย สำาคัญ 6.6% ในภูมิภาคเอเชียแปซิฟิก ได้ รับแรงผลักดันมาจากการฟื้นตัวจากโรค อหิวาต์แอฟริกาในสุกร (ASF) โดยญี่ปุ่น เกาหลีใต้ มาเลเซียและจีนแสดงให้เห็น ถึงการฟื้นตัวจากการระบาดของ ASF ใน ขณะที่อินโดนีเซีย เมียนมาร์ ฟิลิปปินส์
2030 (FEFAC Feed Sustainability Charter 2030)

จากจำานวนเจ้าของสัตว์เลี้ยงเพิ่มมากขึ้น เนื่องจากการแพร่ระบาดของโรคโควิด-19 ในขณะที่ผลผลิตในบางภูมิภาคยังคงทรงตัว และไม่มีรายงานผลผลิตที่ลดลงในภูมิภาค ใดๆ ทั่วโลก
ความเสี่ยงของอุตสาหกรรมอาหาร
และ 2.5% โดย
ไทย และเวียดนาม ยังมีผลกระทบจากการ ระบาดของ ASF ส่วนประเทศในยุโรปที่ไม่ ประสบปัญหา ASF หรือแก้ไขปัญหาลุล่วง ไปแล้วยังคงได้รับผลกระทบจากผลผลิตเนื้อ สุกรส่วนเกินเนื่องจากประเทศจีนมีความ ต้องการลดลง อาหารโคนม อาหารโคนมมีผลผลิตเพิ่มขึ้นทั่วโลก 1.9% โดยน้ำาหนัก กลุ่มเอเชียแปซิฟิกมี แนวโน้มผลผลิตเพิ่มขึ้นมากที่สุด ส่วนใหญ่ มาจากการเติบโตในอินเดีย การล็อกดาวน์ จากการระบาดของโรคโควิด-19
คลายลง อุตสาหกรรมการบริการและการ ศึกษาในชั้นเรียนช่วยเพิ่มการบริโภคนมโดย รวม ออสเตรเลียและนิวซีแลนด์มีผลผลิต อาหารโคนมลดลง 6.7%
น้ำาหนักตามลำาดับ อาหารโคเนื้อ การผลิตอาหารโคเนื้อลดลง 1.9%
โลก ความท้าทายของอุตสาหกรรมมาจาก กฎระเบียบแก๊สเรือนกระจก (GHG) และ การรับรู้เกี่ยวกับผลกระทบต่อสิ่งแวดล้อมและ สุขภาพ ตลาดยุโรปมุ่งเน้นไปที่การลดการ ปล่อยแก๊สเรือนกระจกเพื่อให้สอดคล้องกับ การประชุมสมัชชาประเทศภาคีอนุสัญญา สหประชาชาติว่าด้วยการเปลี่ยนแปลง สภาพภูมิอากาศ (COP26) ข้อตกลงสี เขียวของสหภาพยุโรป (EU Green Deal) และกฎบัตรความยั่งยืนอาหารสัตว์
สหรัฐอเมริกาได้รับผลก ระทบจากวัวหนุ่มที่ตอนแล้วและปริมาณแม่ วัวสาวที่สะสมมาจากปี 2563 รวมถึงความ ต้องการส่งออกเนื้อวัวที่สูงเป็นประวัติการณ์ อาร์เจนตินามีผลผลิตลดลงอย่างมีนัยสาคัญ เนื่องจากการส่งออกที่ลดลงและอัตราเงินเฟ้อ สูง และเงินเปโซที่อ่อนค่าลงส่งผลกระทบต่อกาลังซื้อของชาวอาร์เจนตินา อาหารสัตว์น้ำา อุตสาหกรรมการเพาะเลี้ยงสัตว์น้ำายังคง เติบโตอย่างต่อเนื่องในหลายตลาด และมี การขยายตัวอย่างน่าพอใจที่ 3.7% ระบบ การเพาะเลี้ยงสัตว์น้ำาหมุนเวียน (RAS) กา ลังเป็นที่นิยมมากขึ้น และความต้องการ ปลาของผู้บริโภคเพิ่มขึ้น ตลาดที่มีปัญหา จากโรคอหิวาต์แอฟริกาในสุกรทำาให้ปริมาณ เนื้อสุกรลดลงจะมีการเติบโตของสัตว์น้ำามาก ขึ้น อินเดียมีการขยายตัวของอาหารสัตว์ น้ำาอย่างมีนัยสาคัญ นอกจากนั้น ตลาด อินโดนีเซียมีสัดส่วนถึง 10% ของการเติบโต ในภูมิภาคเอเชียแปซิฟิก ส่วนชิลี บราซิล ฮอนดูรัส และเอกวาดอร์มีส่วนในการเติบโต ของละตินอเมริกา 5.6% อาหารสัตว์เลี้ยง การผลิตอาหารสัตว์เลี้ยงเพิ่มขึ้นสูงสุด เมื่อเทียบกับทุกกลุ่ม โดยมีผลผลิตเพิ่มขึ้น 8.2% การเพิ่มขึ้นอย่างมีนัยสาคัญนี้เกิด
ที่ผ่อน
ทั่ว
FEFAC
สัตว์ในปัจจุบัน ศูนย์วิเคราะห์เศรษฐกิจ ธนาคารทหารไทย ธนชาต เสนอปัจจัยเสี่ยงของอุตสาหกรรม อาหารสัตว์ โดยสรุปดังนี้ - ความผันผวนของราคาตลาดโลกของ วัตถุดิบผลิตอาหารสัตว์ เช่น ข้าวโพด ข้าว สาลี ถั่วเหลือง - กระแสความต้องการผลิตภัณฑ์จาก สัตว์ที่ผ่านกรรมวิธีผลิตตามธรรมชาติ - โรคระบาดในสัตว์ต่างๆ เช่น โรค อหิวาต์แอฟริกาในสุกร ไข้หวัดนกในไก่ โรคตายด่วนในกุ้ง อาหารสัตว์ที่ใช้เลี้ยงส่งผลกระทบต่อปริมาณ
The feed industry is a midstream industry connecting the agricultural sector and the animal production sector. Incidents in the animal production industry such as insufficient raw materials, lack of technology, quality and safety issues inevitably affects downstream industries and finally food security.

The TTB analytics presented its analysis of the feed industry in 2019 - 2022 that the feed industry in Thailand is worth 260 billion baht in 2019. During this 5 years-period, the growth is up to 7-10% per year. In 2019, feed production was 20.2 mmt, poultry feed production was the highest at 11.4 mmt, followed by swine feed at 5.5 mmt, aquaculture feed at 1 mmt, and cattle feed at 0.9 mmt. In 2020 – 2022, the feed industry is expanding due to the continuous increase in demand for meat. In 2021 The Department of Livestock Development reported that pet food has been exported steadily. The most exported volumes are canned pet food products and pet food pellets, accounting for 55% and 41% respectively.
Global Feed Productions and Trends
The 2022 Alltech Agri-Food Outlook highlights global feed production survey data. The global COVID-19 pandemic has had major impacts on the agri-food sector, contributing to supply chain challenges and accelerating the adoption of new technology and environmental sustainability practices. It is estimated that international feed tonnage has increased by 2.3%, to 1.235 billion metric tons of feed produced in 2021. The top ten feed-producing countries over the past year were China (261.424 mmt), the U.S. (231.538 mmt), Brazil (80.094 mmt), India (44.059 mmt), Mexico (38.857 mmt), Spain (35.580 mmt), Russia (33.000 mmt), Turkey (25.300 mmt), Japan (24.797 mmt) and Germany (24.506 mmt).
The country with the largest increase in feed production by tonnage was China by 8.9% to 261.424 mmt. A key trend resulting in this growth was the continuation of the consolidation and modernization of the country’s feed industry. Swine farms and feed production have moved from utilizing food waste to contracting with professional feed mills. As a result, commercial feed tonnage increased, driven in particular by the growth and continued modernization of the pig sector.
Chicken feed
The poultry (chicken) sector experienced a slight reduction in layer feed tonnage (down 1.4%), whereas broiler feed production increased from 2021 (by 2.3%). The layer business
has been facing challenges in many countries due to the high costs of raw materials, combined with flat/ low retail prices for eggs. Animal welfare concerns are also a driver, as cage-free and free-range production are on the rise in many countries. In Europe, the most significant decreases occurred in Norway, Russia, Ukraine and Poland. Asia-Pacific also saw a decrease, while tonnage in Australia grew by 4%.
Factors that have aided the broiler sector include an increased demand for easy-to-cook proteins as restaurants closed during the pandemic and an affordable protein option, as the prices of other meat proteins increased. China and India accounted for the most significant increases in Asia-Pacific. In Latin America, Peru, Brazil, Paraguay and Mexico contributed significantly to the region’s 5% increase.
Pig feed
Pig feed production increased significantly, by 6.6%, which was primarily boosted by Asia-Pacific’s recovery from African swine fever (ASF). Japan, South Korea, Malaysia and China demonstrated just such a recovery from ASF, but Indonesia, Myanmar, the Philippines, Thailand and Vietnam continued to feel the impact of the disease. In Europe, countries where ASF is not or is no longer a problem were still impacted by a pork surplus due to a reduced demand from China.
Dairy feed
Dairy feed tonnage increased slightly, by 1.9%. Asia-Pacific saw the biggest increase, which is mostly attributed to growth in India. As COVID-19 lockdowns eased around the world, the reopening of the hospitality industry and in-
person classroom education helped boost milk consumption overall. In Australia and New Zealand, dairy feed tonnages were down 6.7% and 2.5%, respectively.
Beef feed
Beef feed production shrunk by 1.9% globally. The industry continues to be challenged by GHG regulations and perceptions of environmental and health impacts. European markets are especially focused on reducing GHG emissions to align with the UN Climate Change Conference of the Parties (COP26), the EU Green Deal and the FEFAC Feed Sustainability Charter 2030. The U.S. experienced an increased steer and heifer harvest due to carryover from 2020, as well as a record demand for beef exports. Argentina saw a significant reduction due to reduced exports, and high inflation and the devaluation of the local currency are also affecting Argentinians’ purchasing power.
Aquaculture feed
The aquaculture industry continues to grow in many markets and increased by an impressive 3.7%. Recirculating aquaculture systems (RAS) are becoming more prevalent, and consumer demand for fish is on the rise. Markets with ASF challenges saw additional growth due to their reduced pork supply. India saw a significant increase in its aquaculture feed tonnage of 9%; additionally, Indonesia accounted for 10% of Asia-Pacific’s growth. In Latin America, Chile, Brazil, Honduras and Ecuador contributed to the regional growth of 5.6%.
Pet food
Pet food production had the highest increase among the sectors, with an 8.2% rise in production. This significant increase is largely due to the rise in pet ownership amid the COVID-19 pandemic. While some regions remained flat, there were

25 Mar-Apr
no reported decreases in any region around the world.
Current Animal Feed Industry Risks
The ttb analytics proposed the risk factors of the animal feed industry which are summarized as follows:
- Fluctuation of global market prices of feed raw materials such as corn, wheat, soybeans
- Trends in demand for organically sourced meat/dairy products
- Diseases in animals such as ASF, avian influenza in chickens, early mortality syndrome (EMS) in shrimp, affecting the amount of feed uses
- The economic slowdown of major export countries and competition in the global market of food products
However, ttb still saw supporting factors of the animal feed industry, including continuous increase in consumption of animal products, including swine, chicken, and aquatic animals, as well as investment in industrial scale farming are on the rise.
Haze Pollution from Agricultural Sector
Haze pollution in Thailand has been occurring for more than 10 years from various causes; including transportation sector, industrial sectors, and agricultural sector. In the large-scale crop production, biomass is burned after harvest which worsens the situation. Corn, a key raw material for feed production, was also reported to be a major source of haze. Biomass remains on sloping hillsides are difficult to plough by tractors. On the other hand, burning is a quick and low-cost solution.
Greenpeace Thailand reported that feed corn and contract farming in the Northern region are causes. Satellite images taken between 2015 and 2020 presents that corn is
the major cause of haze pollution. Image analysis found that burning area and hotspots occurred one-third on corn crops area. For more than 15 years, 10.6 million Rais of forest in the Mekong sub-region has been transformed into crop area. Half of the area is in the Northern region of Lao PDR.
The Russian Invasion
The impacts of the Russia invasion on Ukrainian corn and wheat supply are reassessed at the war’s one-year anniversary. Ukraine’s corn and wheat production and exports are of broad interest because they comprise a significant share of the global market for these crops. Overall, corn and wheat exports from Ukraine in the 2021/22 marketing year were down 20% from projections made before the conflict. For 2022/23, large declines in exports of approximately one-half to two-thirds were initially anticipated but those initial worst fears about lost or stranded Ukrainian agricultural supplies have not been realized. After spiking in the months following the start of the war, commodity prices have moderated to pre-war levels which remain high in historic terms. Going forward, corn and wheat markets will balance supply response to high prices occurring in other major production regions with the prospects for continued warinduced supply losses in Ukraine. Ukraine’s exports made up 15% of world corn trade and 10% of world wheat trade. In this period, Ukraine was the world’s fourth largest corn exporting country and the fifth largest wheat exporting country. However, the Russo-Ukrainian War still show no sign of ending. The feed industry that uses imported raw materials shall be concern and establish plans to deal with price crises,
although its supplies are not directly imported from Ukraine (or Russia).
Future Challenges
Feed & Grain asked the American Feed Industry Association (AFIA) and the National Grain and Feed Association (NGFA) what they saw as their top three challenges for the 2023 North American animal feed industry, and, of course, they are applicable to the global situations.
1. Ongoing supply chain crunch
The supply chain became turbulent during COVID and never fully righted, workforce shortages and disputes, and climate issues stepped in to create more challenges. The ongoing war in Ukraine also continued to impact supply chains, boosting corn and wheat prices.
2. Labor challenges intensify
The pandemic caused a major disruption in the North American labor force. Competition for qualified candidates is fierce and continues to fuel a worker shortage. Finding qualified people to work in their manufacturing facilities is a problem, despite increased financial incentives.
3. Continuing global inflation
Slowing national economies in top markets point to the likelihood of a global recession. The International Monetary Fund (IMF) stated in its October 2022 World Economic Outlook Report that the global economy will grow 3.2% by the end of the year but forecasts only a 2.7% expansion in 2023. The report went on to say that one-third of the world’s economies are technically already in a recession, defining this distinction by contractions spanning two consecutive quarters. Global inflation is forecast to decrease to 6.5% in 2023 after hitting 8.8% at the end of 2022, says the IMF.
26 www.innolabmagazine.com
adithep.k@si-ware.com

The rugged and easy-to-use handheld NeoSpectra Scanner brings lab-grade material analysis to measures protein, oil, moisture and more in seconds in the production line or field. Thousands of ready-to-use models from the NeoSpectra LabStore get you up and running quickly. Powered by the NeoSpectra Scan mobile application, you can be analyzing samples accurately only 3 easy steps:
1. Download the Scan Apps to mobile.
2. Connect scanner with Bluetooth.
3. Select calibrations from the NeoSpectra LabStore and Ready!
The NeoSpectra Scanner is like a laboratory in your hand ready to bring instant insights into your process or production line to ensures reliable results from anywhere. For more information, please visit https://www.si-ware.com/

เครื่องวิเคราะห์คุณสมบัติของตัวอย่างแบบพกพา ด้วยเทคนิค Fourier Transform Near Infrared (FT-NIR) จึงสามารถทำาการวิเคราะห์ได้หลากหลาย เช่น %Moisture, %Fat, %Protein ฯลฯ พร้อมๆ กันภายในเวลาเพียงไม่กี่วินาที ด้วยการออกแบบ มาให้เหมาะกับการใช้งานทั้งในสายการผลิตและภาคสนาม พร้อมสร้างความมั่นใจให้ คุณด้วย LabStore ของเรา และยังสามารถใช้งานบนมือถือร่วมกับ NeoSpectra Scan เพื่อความรวดเร็วและแม่นยำา เพียง 3 ขั้นตอนง่ายๆ 1. ดาวน์โหลด Scan Apps ลงในมือถือ 2. เชื่อมต่อเครื่องสแกนด้วยบลูทูธ 3. เลือกการสอบเทียบผ่าน NeoSpectra LabStore NeoSpectra Scanner ห้องปฏิบัติการแบบพกพาที่พร้อมจะนำาข้อมูลเชิงลึกใน กระบวนการและสายการผลิต
https://www.si-ware.com/
เพื่อสร้างความมั่นใจในผลลัพธ์ที่เชื่อถือได้ในมือคุณ สามารถศึกษาข้อมูลเพิ่มเติมได้ที่
NEOSPECTRA SCANNER HANDHELD NIR ANALYZER by Si-Ware Systems Inc.
FEATURES
Thailand Industry Outlook

2021-23: Medical Devices
ปี 2564 มูลค่าจำาหน่ายเครื่องมือแพทย์ในประเทศจะเติบโตใกล้เคียงกับปี 2563 ขณะที่ตลาดส่งออกจะเติบโตได้ในเกณฑ์สูงต่อ
ผลิตภัณฑ์ในกลุ่มวัสดุสิ้นเปลืองประเภทใช้แล้วทิ้งมีแนวโน้มเติบโตได้ต่อเนื่องทั้งตลาดในประเทศและตลาดส่งออก
ปี 2565-2566 คาดว่าความต้องการ อุปกรณ์การแพทย์ที่เกี่ยวข้องกับสุขอนามัย และการดูแลสุขภาพยังเพิ่มขึ้นต่อเนื่องทั้ง ตลาดในประเทศและต่างประเทศ โดยได้ อานิสงส์จาก (1) อัตราการเจ็บป่วยมีแนวโน้มเพิ่ม
25652566 หลังจากหดตัวถึง 97% ในปี 2564
(3) ผู้ประกอบการโรงพยาบาลมีแผน
(4) กระแสการใส่ใจสุขภาพและความ ต้องการดูแลสุขภาพแบบครบวงจรมีแนว โน้มเพิ่มขึ้นทั่วโลกรวมถึงไทย
(5) เศรษฐกิจประเทศคู่ค้าหลักของไทย
หลอด/เข็มฉีดยา (6) นโยบายสนับสนุนจากภาครัฐใน
ลักษณะคงทนถาวร มีอายุการใช้งานไม่ต่ำา กว่า 1 ปี ตัวอย่างผลิตภัณฑ์ เช่น หีบและ ชุดปฐมพยาบาล รถเข็นผู้ป่วย เตียงคนไข้ อุปกรณ์และเครื่องใช้ทางวิทยาศาสตร์การ แพทย์ ศัลยกรรม ทันตกรรม เครื่องวินิจฉัย โรคด้วยไฟฟ้า และเครื่องเอ็กซเรย์ เป็นต้น 3) กลุ่มน้ำ า ยาและชุดวินิจฉัยโรค
28 www.innolabmagazine.com
กลับมาใช้บริการในไทยเพิ่มขึ้นในปีจำานวนผู้ป่วยต่างชาติที่มีแนวโน้ม
ขึ้นจากโรคไม่ติดต่อเรื้อรัง (2)
ขยายการลงทุนต่อเนื่อง
ต่อเนื่องโดยเฉพาะในกลุ่มวัสดุสิ้นเปลือง ประเภทถุงมือยาง
การพัฒนาให้ไทยเป็นศูนย์กลางสุขภาพ
เนื่อง การแพร่ระบาดของไวรัส COVID-19 ที่รุนแรงขึ้นในปี 2564 แม้จะส่งผลให้จำานวนนักท่องเที่ยวเชิงการแพทย์ (Medical Tourism) และผู้เข้ารับบริการในสถานพยาบาลสำาหรับโรคที่ไม่เร่งด่วนปรับลดค่อนข้างมาก
ความต้องการใช้
อาทิ ถุงมือ ยางทางการแพทย์ หน้ากากอนามัย หลอด/เข็มฉีดยา หลอดสวน และแกนสอด นานาชาติ (Medical Hub) สำาหรับปัจจัย ท้าทายทางธุรกิจที่สำาคัญคือ การแข่งขันที่ มีแนวโน้มรุนแรงขึ้น จากการที่ผู้ประกอบ การไทยมีข้อจำากัดในการพัฒนาเทคโนโลยี ขั้นสูง จึงต้องพึ่งพาการนำาเข้าหรือการผลิต จากผู้ประกอบการต่างชาติที่เข้ามาตั้งฐาน การผลิตในไทย ข้อมูลพื้นฐาน อุตสาหกรรมเครื่องมือแพทย์ครอบคลุม ทั้งเครื่องมือแพทย์และอุปกรณ์ทางการแพทย์ มีมูลค่ารวมคิดเป็น 1.2% ของ GDP (ปี 2563) เนื่องตามการเพิ่มขึ้นของจำอุตสาหกรรมมีทิศทางเติบโตต่อ านวนผู้ป่วยและ ผู้สูงอายุ และเนื่องจากเป็นสินค้าจำาเป็นที่มี ความสำาคัญต่อสุขภาพ จึงมีความอ่อนไหว ต่อภาวะเศรษฐกิจค่อนข้างจำากัด เครื่องมือแพทย์และอุปกรณ์ทางการ แพทย์ จำาแนกตามลักษณะการใช้งานได้ เป็น 3 กลุ่ม คือ Author info นรินทร์ ตันไพบูลย์ Narin Tunpaiboon, Krungsri Research narin.tunapaiboon@krungsri.com +66 2 296 2943 INDUSTRY MOVEMENT
ยังมีความต้องการอุปกรณ์ทางการแพทย์
อย่างไรก็ตาม
1) กลุ่มวัสดุสิ้นเปลืองทางการแพทย์ (Single-use device) เป็นผลิตภัณฑ์เพื่อ การรักษาพยาบาลทั่วไป ใช้เทคโนโลยีการ ผลิตไม่สูง มักเป็นการใช้ครั้งเดียวหรือใช้แล้ว ทิ้ง อาทิ หลอดฉีดยา เข็มฉีดยา สายยาง หลอดสวน แกนสอด ถุงมือยาง/ถุงมือยาง ทางการแพทย์ อุปกรณ์และเครื่องใช้อื่นๆ ทางทันตกรรม และอุปกรณ์และเครื่องใช้ อื่นๆ ที่เกี่ยวกับนัยน์ตา 2) กลุ่มครุภัณฑ์ทางการแพทย์ (Durable medical device) เป็นผลิตภัณฑ์ที่มี
(Reagent and test kit) ได้แก่ ผลิตภัณฑ์ น้ำ า ยาเพื่อใช้เตรียมหรือเก็บตัวอย่างจาก ร่างกาย (อาทิ น้ำายาทดสอบกรุ๊ปเลือด
Figure: Trade Value of Thai Medical Device (2020)
(Electrodiagnostic devices) เครื่องมือแพทย์ที่
(Orthopedic and fracture devices) เครื่องเอ็กซเรย์
ติดเชื้อที่เพิ่มขึ้นมากตามความต้องการใช้ ส่งผลให้กลุ่มวัสดุสิ้นเปลืองทางการแพทย์ (สัดส่วน 28.3%) และกลุ่มน้ำายาและชุด วินิจฉัยโรค (สัดส่วน

ตามลำาดับ

29 Mar-Apr และชุดน้ำายาล้างไต) ชุดตรวจวินิจฉัยโรค เพื่อการเฝ้าระวังการเกิดโรค (เช่น โรคที่ เกี่ยวกับหลอดเลือดหัวใจ) ชุดทดสอบการ ตั้งครรภ์ ชุดตรวจการติดเชื้อ HIV และชุด ตรวจสารปนเปื้อนในอาหาร ประเทศผู้ผลิตเครื่องมือแพทย์ที่สำาคัญ ของโลก ได้แก่ สหรัฐฯ เป็นรายใหญ่ที่มี รายได้จากการจำ า หน่ายมากที่สุดในโลก (ตารางที่ 1) โดยมีฐานการผลิตกระจาย อยู่ในภูมิภาคต่างๆ ส่วนใหญ่เป็นการ ผลิตกลุ่มผลิตภัณฑ์ที่มีมูลค่าสูง อาทิ เครื่องวินิจฉัยโรคด้วยไฟฟ้า
ใช้ในการศัลยกรรมกระดูก
(X-ray devices) และเครื่องมือทาง ทันตกรรม เยอรมนี และเนเธอร์แลนด์ ได้ รับการยอมรับทั้งด้านคุณภาพและการพัฒนา คิดค้นเทคโนโลยี โดยเฉพาะเยอรมนีมีการ ปรับกระบวนการผลิตด้วยนวัตกรรมใหม่ๆ อย่างต่อเนื่อง ส่วนในเอเชีย ประเทศสำาคัญ ได้แก่ ญี่ปุ่น จัดเป็นประเทศที่มีศักยภาพใน การผลิตเครื่องมือแพทย์ และเป็นศูนย์กลาง นวัตกรรมด้านเทคโนโลยีเครื่องมือแพทย์ ที่ทันสมัยซึ่งได้รับการยอมรับจากทั่วโลก สำาหรับจีนและอาเซียน การผลิตส่วนใหญ่ เป็นผลิตภัณฑ์กลุ่มวัสดุสิ้นเปลือง ในขณะที่ เครื่องมือแพทย์ที่ใช้เทคโนโลยีสูงยังจำาเป็น ต้องนำาเข้าจากต่างประเทศโดยเฉพาะสหรัฐฯ เยอรมนี และญี่ปุ่น ปี 2563 มูลค่าการค้าของเครื่องมือ และอุปกรณ์การแพทย์ในตลาดโลก (ผล รวมของมูลค่าการส่งออกและนำาเข้า) หด ตัว 9.7% จากปี 2562 ผลจากการแพร่ ระบาดของ COVID-19 ทำาให้ความต้องการ ส่วนใหญ่กระจุกตัวอยู่ในเครื่องมือแพทย์ที่ จำาเป็น ขณะที่ประเทศส่วนใหญ่ผลิตเพื่อตอบ สนองความต้องการใช้ภายในเป็นลำาดับแรก โดยผลิตภัณฑ์กลุ่มครุภัณฑ์ทางการแพทย์ มีสัดส่วนสูงสุด 66.3% ของมูลค่าการค้า เครื่องมือแพทย์ทั่วโลก หดตัว 20.5% อย่างไร ก็ตาม ความต้องการสินค้าที่ใช้ป้องกันการ
5.5%) เพิ่มขึ้น 23.8% YoY และ 20.5% YoY ตามลำาดับ ด้าน ผู้ส่งออกเครื่องมือแพทย์รายใหญ่ของโลก (ภาพที่ 3) ได้แก่ จีน (สัดส่วน 14.7% ของมูลค่าส่งออกเครื่องมือแพทย์ทั่วโลก) ซึ่งเน้นส่งออกวัสดุสิ้นเปลืองทางการแพทย์ รองลงมา คือ เยอรมนี (14.1%) สหรัฐฯ (9.8%) และญี่ปุ่น (6.8%) (ปี 2562 ส่ง ออกอันดับ 1 คือ เยอรมนี (สัดส่วน 14.1%) รองลงมา คือ สหรัฐฯ และญี่ปุ่น ซึ่งเป็นกลุ่มที่เน้นส่งออกครุภัณฑ์ทางการ แพทย์) ด้านผู้นำาเข้าเครื่องมือแพทย์ราย ใหญ่ ได้แก่ สหรัฐฯ (สัดส่วน 22.1% ของ มูลค่านำาเข้าเครื่องมือแพทย์ทั่วโลก) รอง ลงมา ได้แก่ เยอรมนี (8.8%) จีน (6.5%) และฝรั่งเศส (5.2%) ส่วนไทยเป็นประเทศ ที่ส่งออกและนำาเข้าเครื่องมือแพทย์ลำาดับ
90.0% อาทิ ถุงมือยาง/ถุงมือยางทางการแพทย์ หลอด สวนและหลอด/เข็มฉีดยา และอุปกรณ์ทำา แผล ตลาดส่งออกหลัก ได้แก่ สหรัฐฯ ญี่ปุ่น เนเธอร์แลนด์ และเยอรมนี ด้านผู้ประกอบ การที่ทำาการผลิตและส่งออกส่วนใหญ่เป็น บริษัทข้ามชาติ (เช่น ญี่ปุ่น สหรัฐฯ และ ฝรั่งเศส) ที่เข้ามาลงทุนในไทยเพื่อเป็นฐาน การผลิตและส่งออกสู่ภูมิภาคอื่น สำาหรับ ผลิตภัณฑ์นำาเข้า ส่วนใหญ่เป็นกลุ่มครุภัณฑ์ และวัสดุสิ้นเปลืองทางการแพทย์ (สัดส่วน รวมกันประมาณ 80.7%) อาทิ เครื่องอัลตรา ซาวนด์ เครื่องเอ็กซเรย์ เครื่องตรวจวัดคลื่น หัวใจ เครื่องตรวจคลื่นไฟฟ้าในสมอง และ ผลิตภัณฑ์ทางจักษุวิทยา ส่วนใหญ่เป็นการ นำาเข้าจากสหรัฐฯ จีน เยอรมนี และญี่ปุ่น
ที่ 19 (สัดส่วน 1.2%) และ 32 (สัดส่วน 0.5%) ของโลก
การส่งออกเครื่องมือแพทย์ของไทยอยู่ ในกลุ่มวัสดุสิ้นเปลืองประมาณ
Figure: Thai Medical Device Manufacturers
Table: Major Domestic Medical Device Manufacturers
The domestic market for medical devices will expand through 2021 at a rate that will closely mirror that of a year earlier, while exports will continue to enjoy strong growth, and although the severity of Thailand’s 3rd wave of Covid-19 infections has temporarily closed the market for medical tourism and severely undercut the number of domestic patients seeking treatment for less severe conditions, demand for single-use consumables (e.g., latex gloves, surgical masks, syringes, catheters and cannulas) remains on an upward track on both the domestic and export markets.
Over 2022 and 2023, demand for medical devices connected to healthcare and hygiene will increase at home and abroad, supported by:
(i) rising rates of ill-health due to the increasing prevalence of noncommunicable diseases;
(ii) a rebound in the number of foreign patients coming to Thailand for treatment (admissions crashed -97% in 2021);
(iii) ongoing investment in hospitals by private-sector healthcare providers;
(iv) growing interest in health and wellness by consumers worldwide, including those in Thailand;
(v) ongoing demand in Thailand’s main export markets for medical devices and equipment, in particular for latex gloves and syringes/hypodermic needles; and
(vi) government policy to promote Thailand as an international medical hub. However, Thai players’ weaknesses in developing high-tech applications and products means that in some product categories, the country is dependent on products sourced abroad and then imported and/or those supplied by foreign operations that have set up production facilities in Thailand, and this situation will tend to stoke more intense competition.
Overview
The medical devices sector includes both medical devices and medical equipment. Considered a high-value industry, accounting for 1.2% of GDP in 2020. The sector has continued to grow in tandem
with the rising number of patients and and aging population. Because the products are considered life essentials, the sector is also resilient to changes in economic conditions.
Medical devices and medical equipment can be divided into three categories according to use.
1) Single-use devices are used in general medical treatments and normally not high-tech. The items are meant to be disposed after use. Examples include syringes, hypodermic needles, tubes, catheters, cannulas, disposable gloves and some items used in dentistry or ophthalmology.
2) Durable medical devices normally have a life-span of at least one year. Examples include first aid kits, wheelchairs, medical beds, technical equipment used in medicine, surgery and dentistry, electrical diagnostic tools, and x-ray machines.
3) Reagents and test kits include equipment used to diagnose illnesses and conditions and chemical kits used to test samples drawn from patients. For example, to test for blood type before dialysis, pregnancy tests, and to detect HIV infection.
The world’s most important producer of medical devices is the US, and the country therefore enjoys the greatest income from the distribution of medical devices of any nation. Although production facilities operated by US corporations are geographically dispersed, output from these is focused on high-value
products, such as electro-diagnostic devices, equipment used in orthopedic and fracture-treatment settings, X-ray machines, and dental equipment. Also well regarded for the quality of their cutting-edge products are Dutch and German manufacturers, the latter in particular earning plaudits for their ongoing innovation of production processes. Within Asia, given its role as another world-leading center of innovation, Japan is widely regarded as a leader in the medical devices industry, while players in China and the ASEAN zone tend to be much more heavily focused on the production of consumables. In these countries, high-tech appliances need to be imported, most often from the US, Germany and Japan.
In 2020, the value of medical devices traded on the global market (combined imports and exports) contracted by 9.7% down from in 2019. The spread of Covid-19 outbreak drives demand for essential medical devices. Products will be prioritized to serve domestic market. The majority of these products were durable items which comprised 66.3% of total global trade, but the value in global market shrank by 20.5%. However, demand for protective equipment continued to rise on higher demand. As a result, single-use device (28.3%) and reagent and test kits (5.5%) rose by 23.8% YoY and 20.5% YoY, respectively. On export side, in global market, large medical device exporter in 2020 was China
32 www.innolabmagazine.com
(14.7% of global medical device exports), targeting single-use devices; followed by Germany (14.1%), the US (9.8%) and Japan (6.8%). In 2019, the world’s largest exporters were Germany (14.1%), followed by the US and Japan focusing on durable medical devices. The largest importer was the US (22.1% of total global imports of medical devices), followed by Germany (8.8%), China (6.5%), and France (5.2%). Thailand ranked as the world’s 19th exporter of medical devices (1.2%) and 32nd importer of medical devices (0.5%).
Thailand’s exports of medical devices mostly were single-use devices (e.g. rubber gloves, medical rubber gloves, catheters and medical tubing, syringes and hypodermic needles, and bandages and dressings). which accounted for 90.0% of export value. Thailand’s key export markets are the US, followed by Japan, the Netherlands, and Germany. Most of the manufacturers and exporters in Thailand are foreign-owned companies using Thailand as production base to export to other region, e.g. Japan, the US and France. Looking at imports, these were mostly durable medical items and single-use devices (a combined 80.7% of total import

value) e.g. ultrasound equipment, x-ray machines, electrocardiogram (ECG) and electroencephalogram (EEG) monitors, and ophthalmological equipment. The major sources of imports were the United States, China, Germany, and Japan.
965 producers of medical devices are registered with the Department of Business Development (as of June 2021). Of this, 98.0% are SMEs which recorded a combined 19.1% share of total revenue. Another 2.0% are large manufacturers which command 80.9% of total revenue (2019). Most of those (large manufacturers) are multinational companies (MNCs). They include Nipro (Thailand), Hoya Optics (Thailand), and Kawasumi Laboratories (Thailand). Meanwhile, there are over 2,000 registered importers of medical devices, according to data from the Food & Drug Administration.
Outlook
Krungsri Research sees the domestic and export markets for medical devices expanding in value by respectively 5.7% and 30-35% in 2021. Demand for personal protective equipment (PPE) will continue to strengthen, especially for disposable
medical gloves, as will consumption of solutions and diagnostic kits. The government is also working to widen export distribution channels, for example by developing online business matching opportunities for sellers and buyers of medical devices and protective equipment (e.g., PPE suits, syringes, sealed capsules for moving Covid-19 patients in and out of CT scans, and disposable PPE equipment for use in hospitals).
Looking out to 2022 and 2023, Krungsri Research’s analysis indicates that growth in the value of medical devices distributed to the domestic market should average 5.0-7.0% annually. The market will be helped by the completion of the national vaccination program and the suppression of the spread of Covid-19 that this will bring, as well as by economic recovery, even if this is only somewhat sluggish. As the pandemic abates and the economy improves, the number of individuals seeking treatment in hospitals should return to normal levels, and this will naturally underpin stronger demand for medical devices. On export markets, growth is likely to slow from the breakneck pace set over 2020 and 2021 (thanks to the Covid-driven spike in demand for single-use medical devices and especially for latex gloves) to a still impressive 8.0% per year (Figure 13). Individual factors supporting growth in the industry are described below.
1) health is expected to worsen among the Thai population due to rising rates of non-communicable diseases (NCDs)
2) Following the -97% slump in admissions in 2021, the number of foreign patients seeking treatment in Thai hospitals is forecast to rebound in 2022 and 2023
33 Mar-Apr
Figure: Thai Medical Device Trade
3) To meet increased demand from Thai and overseas patients, many private hospitals plan to increase investments
4) Interest in personal health and wellness is growing among consumers worldwide, and Thailand has not escaped this trend.
5) Exports of medical devices from Thailand should increase in step with the improvement in the general economic outlook in overseas markets.
6) The industry has been the beneficiary of government support that has manifested itself in a number of different ways. (i) The government has laid out a plan to establish Thailand as an international medical hub over the years 20172026 and (ii) The government has agreed to the implementation of the “Memorandum of Understanding on the Implementation of NonTariff Measures on Essential Goods under the Hanoi Plan of Action on Strengthening ASEAN Economic Cooperation and Supply Chain Connectivity in Response to the COVID-19 Pandemic”.
7) The industry is also benefiting from the development of the innovative, high-tech medical products that are needed as society addresses the challenges posed by the ongoing transmission and evolution of Covid-19.
Krungsri Research’s evaluation of opportunities for developing markets for each product group is laid out below.
Demand for single-use products will grow steadily, driven by the following:
(i) rising interest in personal health and hygiene and the effects of government measures to combat the spread of Covid-19, for example by requiring health professionals to
wear PPE and wearing face mask in public is required,
(ii) expansion of public health services; and
(iii) the fact that these are general goods that are used widely in daily life and Thailand benefits from ready-access to upstream inputs, as the world’s leading source of rubber (used in the production of disposable medical gloves), a domestic petrochemical industry (which supplies inputs to produce syringes and catheters), and a textile industry (to produce surgical masks). However, competition is rife in this segment, from both Thai producers and producers in China (surgical masks) and Malaysia (surgical gloves).
Markets for durables and reagents & test kits are likely to continue to expand. Demand for durables would grow, underpinned by
(i) government support for community-level health checks, use of mobile testing centers; and
(ii) expansion of existing/ construction of new hospitals, which will raise demand for technology-based medical equipment. For reagents and diagnostic kits, those which are used to check for coronary heart disease is expected to see the strongest growth, will be encourage by export market.
Beyond this, developing domestically-produced medical device that will play more important roles in the future will be medical robots and automation. These will be applied for diagnosis, medical treatment, rehabilitation, artificial organ manufacture; for example, the AI is used for diagnostic radiology, robotic sensor system, and remotelycontrolled robots that assist with micro-surgery, and automated systems. Development of medical robotics
will help reduce dependency on imports of innovations in the long run. In case, the government support for the research & development of commercially viable products in these areas would help to increase the value of exports, reduce dependency on imports, and ensure the sustainable, long-term development of the Thai medical devices industry.
However, alongside the positive factors outlined above, the industry will also need to confront a number of challenges.
(i) Competition will tend to stiffen due to Thai manufacturers’ only limited ability to develop high-tech products, which has then made them reliant on goods that are either imported or manufactured by overseas players that have set up production facilities in Thailand (In the first quarter of 2021, 14 submissions were made to the BOI for investment support from projects based in the medical industries. These had a combined value of THB 13.37 billion, or around a quarter of the value of all submissions made to the BOI for overseas investments in the government’s targeted industries). Some examples of these include Japanese operations that use Thailand as a base for the production of facemasks and diagnostic kits, large-scale jointventures by Korean and Thai players (e.g., between the Korean Genexine and Thailand’s Kingen Holdings to manufacture precursors for use in the production of biologics), and German involvement in the sector (e.g., the joint venture between HAASE Investment and Siam Bioscience to manufacture biological reagents).
(ii) Most players need to source the high-technology manufacturing equipment used on their production lines from other countries and this then exposes them to the risk of
34 www.innolabmagazine.com
exchange rate fluctuations and higher costs for imports.
(iii) Production of medical devices will increasingly be concentrated on innovative, high-tech goods, including products used in the care of the elderly, innovative consumables, implants, and parts for electrical and radiation-based diagnostic equipment.
(iv) Consumption of single-use medical equipment is likely to rise, but although this provides a high degree of protection against the transmission of disease, its use can also create significant environmental problems because although used equipment may be sterilized, the materials from which it is made are almost never biodegradable. In some countries (e.g., China and India) governments are therefore implementing policies to reduce the environmental impact of waste and supporting research into new materials. The use of biodegradable materials will likely play a major role in helping to cut the negative impacts of medical waste, and developing these products will be a challenge that players in the industry will need to surmount.
Krungsri Research’s view
The severity of the 2021 Covid-19 outbreak in Thailand helped to support greater consumption of medical devices on the domestic market, while at the same time, export growth accelerated on stronger demand, especially for PPE used to protect against Covid-19. Over 2022 and 2023, demand for medical devices related to public health and healthcare will continue to strengthen, and this will then support a solid outlook for the industry as a whole.

Manufacturers of medical devices: earning are projected to grow satisfactorily and operators will enjoy steady profits, even as competition strengthens. Manufacturers that distribute medical devices and equipment through healthcare facilities will continue to register higher revenues, especially those sell to hospitals that are expanding operations and investing more on medical equipment. Consumers are also taking a greater interest in their health, and this presents an opportunity for players to develop new products and equipment to meet this burgeoning demand. Operators will also be able to develop export
markets in neighboring countries by taking advantage of the government’s efforts to promote investment in the EEC, to complement plans to turn Thailand into a medical hub and a regional center for the export of medical supplies and equipment. Nevertheless, despite this generally upbeat assessment, competition is rising within the industry as more international companies invest in production facilities in Thailand to export to customers in the third countries (such as Japan, the United States and France), and operators that need to import parts could face higher costs because they may need to employ currency hedging tools.
Distributors of medical devices (including retailers, wholesalers and importers): revenue will grow in the next few years, albeit slowly. The majority of goods distributed are disposable items that are used regularly in healthcare facilities and by the unwell, but competition is worsening due to the large number of SME distributors in the market. They are fighting for space with agents and retailers that are part of a manufacturer’s commercial network and have access to wider and more comprehensive distribution channels. This would cap growth in this segment. However, importers of medical equipment are generally large, efficient operations that are skilled in marketing and cost-management. These players are now increasingly importing medical robots for use in private hospitals, for example to assist with micro-surgery and in the production and management of pharmaceuticals. This will support earning growth in the coming period.
35 Mar-Apr
Figure: Thai Medical Device Trade
Business Development
& Beverage Technology, DKSH Management (Thailand) Limited

063 858 6581
Three Key Changes
Affecting the Shelf Life of Food Products

จำากัด อาหารเน่าเสียได้ตามธรรมชาติ
หมดอายุการเก็บรักษา จึงเป็นเรื่องปกติ ที่ผู้ค้าปลีกจะโปรโมตสินค้าที่ใกล้หมดอายุ เข้าใจที่ดีขึ้นเกี่ยวกับการเปลี่ยนแปลงสำจะเป็นประโยชน์หากผู้บริโภคมีความ
มากเช่นกันโดยเฉพาะผักและผลไม้เนื่องจาก การจัดการด้วยมืออาจทำาให้เกิดการเน่าได้ ความชื้นก็เป็นข้อพิจารณาที่สำาคัญเช่น เดียวกัน เพราะผักที่มีหัวและใบจะสูญเสียน้ำาเมื่อเก็บไว้ในสภาวะความชื้นต่ำา ในทาง กลับกัน อาหารแห้งหากเก็บไว้ในที่มีความชื้น สูงอาจดูดซับความชื้นและทำาให้เสียได้
หากความผันผวนมีมากและอาหารมีการ เปลี่ยนแปลงบ่อยครั้งผ่านการละลายและ การแช่แข็งใหม่ การละลายและการแข็งตัว
36 www.innolabmagazine.com สามการเปลี่ยนแปลงสำาคัญที่ส่งผล ต่ออายุการเก็บรักษาผลิตภัณฑ์อาหาร แต่ละครั้งที่เราซื้ออาหารในร้านสะดวก ซื้อ อย่างเช่นขนมปัง นม โยเกิร์ต และ อาหารพร้อมรับประทานอื่นๆ
เรารู้ว่า ผลิตภัณฑ์เหล่านี้มีอายุการเก็บรักษา
การเก็บรักษา หลังผ่านไปช่วงหนึ่ง คุณลักษณะของ อาหารอย่างน้อยหนึ่งอย่างอาจถึงสภาวะ ที่ไม่พึงประสงค์ โดยเฉพาะอย่างยิ่งเมื่อ
าคัญ
เคมี และจุลชีววิทยาของผลิตภัณฑ์อาหาร ที่อาจส่งผลต่อการรับรสของเราและอาจนำา ไปสู่การบริโภคอาหารที่ไม่ปลอดภัย สาเหตุหลักของการเสื่อมสภาพของ อาหาร ระหว่างขั้นตอนการจัดเก็บและกระจาย สินค้า ผลิตภัณฑ์อาหารต้องเผชิญกับสภาพ แวดล้อมและปัจจัยที่หลากหลาย เช่น ความชื้น อุณหภูมิ ออกซิเจน และแสง ซึ่ง สามารถนำาไปสู่การเสื่อมสภาพของอาหาร องค์ประกอบและส่วนผสมในอาหาร สามารถเปลี่ยนแปลงได้มากมาย นำาไปสู่การ ปฏิเสธของผู้บริโภคหรือกลายเป็นอันตราย การเปลี่ยนแปลงทางเคมี กายภาพ และ จุลชีววิทยามักเป็นสาเหตุสำาคัญของการ เสื่อมสภาพของอาหารและส่งผลต่ออายุ การเก็บรักษาของอาหาร เพื่อค้นหาการ เปลี่ยนแปลงหลักสามอย่างนี้ มักใช้การ ทดสอบทางประสาทสัมผัส และตามด้วย ผู้เชี่ยวชาญด้านการทดสอบอาหารทำาการ ประเมิน กำาหนด และประมาณการอายุ การเก็บรักษาของผลิตภัณฑ์ การเปลี่ยนแปลงทางกายภาพ การเปลี่ยนแปลงทางกายภาพมักเกิด จากการจัดการอาหารที่ไม่ถูกต้องระหว่าง กระบวนการเก็บเกี่ยว
จำาหน่าย
สำ
หรับอาหารแช่แข็ง
ความชื้นและสัมผัสอากาศเป็นปัญหาด้าน คุณภาพที่สำาคัญ เพราะหากช่องแช่แข็งไม่ อยู่ในสภาวะที่เหมาะสมระหว่าง -18 ถึง -20 องศาเซลเซียส อุณหภูมิที่ผันผวนอาจทำาให้เกิดการตกผลึกซ้ำาของน้ำาแข็ง
เกิดเป็นเนื้อทรายที่ลูกค้าส่วนใหญ่ไม่ชอบ
ของไขมันจะมีผลเสียต่อคุณภาพของลูกอม และขนมหวานอื่นๆ
และการเปลี่ยนแปลงหลายอย่างเกิด ขึ้นในอาหารระหว่างการแปรรูปและ
ที่เกี่ยวข้องกับองค์ประกอบทางกายภาพ
แปรรูป และจัด
หลังการเก็บเกี่ยวก็มีความสำาคัญ
า
การสูญเสีย
ทำาให้
Author info พชร สังข์ทอง Potchara
Director,
Food
TESTING & ANALYSIS
Sungtong
potchara.s@dksh.com
การเปลี่ยนแปลงทางเคมี ระหว่างการแปรรูปและการเก็บรักษา อาหาร การเปลี่ยนแปลงทางเคมีหลาย อย่างเกิดขึ้นโดยเกี่ยวข้องกับส่วนประกอบ ภายในอาหารและปัจจัยแวดล้อมภายนอก การเปลี่ยนแปลงเหล่านี้อาจทำาให้อาหาร เสื่อมสภาพและลดอายุการเก็บรักษา
กิจกรรมของเอนไซม์และปฏิกิริยาออกซิเดชัน โดยเฉพาะการออกซิเดชันของไขมันที่เปลี่ยน รสชาติของอาหารและทำาให้เกิดสีน้ำาตาลที่ ไม่เกี่ยวข้องกับเอนไซม์ซึ่งทำาให้รูปลักษณ์ ของอาหารเปลี่ยนไป
า ตาลอย่าง รวดเร็วในอุณหภูมิห้อง
เนส หากไม่เปลี่ยนโครงสร้างทางโมเลกุล ระหว่างกระบวนการปรับสมดุล

นอกจากอุณหภูมิ แล้ว ปัจจัยแวดล้อมอื่นๆ เช่น ออกซิเจน น้ำา และค่าความเป็นกรดด่าง
อัตราการเจริญเติบโตของจุลินทรีย์ในปัจจัย แวดล้อมต่างๆ จุลินทรีย์สามารถขยาย พันธุ์และมีกลไกการป้องกันโดยทั่วไปที่ดี สำาหรับต่อต้านการโจมตีต่างๆ อย่างไร ก็ตาม หลังจากแยกตัวออกจากพืชแล้ว พวกมันสามารถจำานนต่อการเพิ่มจำานวน จุลินทรีย์ได้อย่างง่ายดาย ในทำานองเดียวกัน
พัฒนาลักษณะทางประสาทสัมผัสที่ไม่พึง ประสงค์ และในบางกรณีอาจทำาให้อาหาร ไม่ปลอดภัยต่อการบริโภค การก่อโรคของจุลินทรีย์บางชนิดเป็น ปัญหาด้านความปลอดภัยทางอาหารที่สำาคัญ ในการแปรรูปและจัดการผลิตภัณฑ์อาหาร
37 Mar-Apr
การ เปลี่ยนแปลงทางเคมีที่สำาคัญที่สุดเกี่ยวข้องกับ
ในอุณหภูมิที่เอื้ออำ า นวย ปฏิกิริยาที่
อย่างรวดเร็ว ซึ่งเปลี่ยนแปลงคุณสมบัติ ด้านคุณภาพของอาหาร ผลไม้ที่หั่นแล้วมักจะเป็นสีน้ำยกตัวอย่างเช่น
เนื่องจากปฏิกิริยา ของฟีนอเลสที่มีต่อส่วนประกอบของเซลล์ ถูกปล่อยออกมาระหว่างการตัดเนื้อเยื่อใน ที่ที่มีออกซิเจน เอนไซม์อย่างไลพอกซีจี
สามารถ ส่งผลต่อคุณภาพอาหารได้แม้ในอุณหภูมิ ที่ต่ำากว่าจุดเยือกแข็ง
สามารถ ทำาให้เกิดการเปลี่ยนแปลงที่เป็นอันตราย ในอาหารโดยการเปลี่ยนแปลงทางเคมีถูก กระตุ้นจากเอนไซม์ การมีกรดไขมันไม่อิ่มตัวในอาหารเป็น สาเหตุสำาคัญของการเกิดกลิ่นหืนระหว่าง การเก็บรักษา การเกิดรสชาติที่ผิดปกติ อาจนำ าไปสู่ปฏิกิริยาไม่พึงประสงค์อื่นๆ ซึ่งรวมถึงการสูญเสียวิตามิน การเปลี่ยน สี และการสลายตัวของโปรตีน อัตราการออกซิเดชันของไขมันได้รับ อิทธิพลจากหลายปัจจัย ตัวแปรสำาคัญคือ อุณหภูมิแวดล้อม การมีอยู่ของออกซิเจน สามารถเพิ่มอัตราการออกซิเดชันเนื่องจาก การออกซิเดชันของไขมันเกิดในอัตราสูงด้วย วอเตอร์แอคทิวิตี้ที่ต่ำามาก ในการกำาหนด อายุการเก็บรักษาอาหารที่มีไขมันต้อง ทราบถึงความสำาคัญของกลไกและอัตรา การเกิดปฏิกิริยา นอกจากการออกซิเดชันของไขมัน ปฏิกิริยาเคมีอื่นๆ ยังรวมถึงแสงซึ่งทำาให้ สูญเสียวิตามินและทำาให้เนื้อเปลี่ยนเป็นสี น้ำาตาล แสงทำาให้นมที่เก็บไว้ในขวดโพลี เอทิลีนความหนาแน่นสูงสูญเสียไรโบฟลาวิน การเกิดสีน้ำาตาลที่ไม่เกี่ยวข้องกับเอนไซม์ คือสาเหตุสำาคัญของการเปลี่ยนแปลงคุณภาพ และการสลายตัวของสารอาหารในอาหาร หลายชนิด ปฏิกิริยาการเกิดสีน้ำาตาลประเภท นี้เกิดขึ้นเนื่องจากปฏิกิริยาระหว่างน้ำาตาล รีดิวซ์และกรดอะมิโน ปฏิกิริยาเหล่านี้ส่ง ผลให้สูญเสียความสามารถในการละลาย โปรตีน สีเข้มขึ้น และเกิดรสขม ปัจจัย แวดล้อม เช่น อุณหภูมิ วอเตอร์แอคทิวิตี้ และความเป็นกรดด่างส่งผลต่อการเกิดสี น้ำาตาลที่ไม่เกี่ยวข้องกับเอนไซม์ การเปลี่ยนแปลงทางจุลชีววิทยา ในการพิจารณาอิทธิพลของจุลินทรีย์ที่
เนื้อที่ได้จากการฆ่า สัตว์ไม่สามารถต้านทานจุลินทรีย์ที่เติบโต อย่างรวดเร็วได้ การเติบโตของจุลินทรีย์ ในอาหารส่งผลให้อาหารเน่าเสียด้วยการ
เมื่อรับประทานเข้าไปแล้ว เชื้อซาลโมเนลลาและอีโคไลอาจทำจุลินทรีย์อย่าง าให้เกิด การติดเชื้อ ส่วนเชื้อลิสทีเรีย โมโนไซโตจี เนส, เชื้อแคมไพโลแบคเตอร์, เชื้อราแอส เปอร์จิลลัสฟลาวัส, เชื้อคลอสติเดียม โบ ทูลินัม และเชื้อสแตฟิโลค็อกคัส ออเรียส สร้างสารเคมีในอาหารที่เป็นพิษต่อมนุษย์
เกี่ยวข้องกับเอนไซม์หลายอย่างจะเกิดขึ้น
มีต่ออายุการเก็บรักษาอาหาร ต้องทราบ
Each time we purchase food in convenience stores such as bread, milk, yogurt, and other ready-to-eat food, we know that these products have a limited shelf life. Food is perishable by nature and numerous changes take place in food during processing and storage.
After a certain period, one or more attributes of food may reach an undesirable condition, particularly as it reaches the end of its shelf life. It is also common for retailers to promote items that are nearing expiry.
It is useful for consumers to have a better understanding of the key changes involving the physical, chemical, and microbiological composition of food products that may affect our sensors and potentially lead to unsafe food consumption.
Main Reasons for Food Deterioration
During the storage and distribution process, food items are exposed
to a wide range of environmental conditions and factors like humidity, temperature, oxygen, and light, which can all lead to food degradation.
The composition and ingredients in food could be altered extensively leading to rejection by consumers or becoming harmful. Chemical, physical, and microbiological changes are often the leading causes of food deterioration and affect the shelf life of food. To determine these three major changes, sensory testing is often used and followed by food testing experts to evaluate, determine, and estimate the item’s shelf life.
Physical Changes
Physical changes are often caused by the mishandling of food during the harvesting, processing, and distribution process. Post-harvesting is also very critical especially with fruits and vegetables as manual handling can lead to the development of rot.

Humidity too is an important consideration as tuberous and leafy vegetables lose water when kept in low humidity conditions. Dry foods on the other hand if kept in high humidity may absorb moisture and become damp.
For frozen food, freezer burn is a major quality concern with frozen food because if the freezer does not meet the optimum condition between -18 and -20 degree Celsius, the fluctuating temperature may cause recrystallization of ice resulting in a sandy texture that is not to most customers’ liking. If fluctuations are large and the food undergoes frequent changes through thawing and refreezing of food, the melting and solidifying of fats are detrimental to the quality of candies and other confectionary items.
Chemical Changes
During the processing and storage of foods, several chemical changes
38 www.innolabmagazine.com การปรากฏตัวของเชื้อราและการเติบโต ของพวกมันบนผลิตภัณฑ์อาหารอาจทำาให้ มีลักษณะที่ไม่พึงประสงค์และรสชาติผิด ปกติ ภายใต้เงื่อนไขบางประการ สปอร์ ของเชื้อราอาจผลิตสารเคมีที่เป็นพิษต่อ มนุษย์ด้วย
การแปรรูปและการเก็บรักษาอาหารเพื่อลด หรือป้องกันการเกิดจุลินทรีย์ที่ทำาให้เกิดโรค และการเน่าเสีย มาตรการต่างๆ ที่ใช้กันทั่วไปเพื่อลด หรือป้องกันการเติบโตของจุลินทรีย์ในอาหาร ได้แก่การเปลี่ยนแปลงอุณหภูมิแวดล้อม โดยการลดอุณหภูมิเพื่อชะลอการเติบโต หรือการเพิ่มอุณหภูมิ แนวทางอื่นได้แก่ การกำาจัดน้ำาเพื่อหยุดการเจริญเติบโตของ จุลินทรีย์ การควบคุมแก๊สในสิ่งแวดล้อม ด้วยการลดออกซิเจนหรือเพิ่มความเข้มข้น ของคาร์บอนไดออกไซด์ เติมกรด และส่ง เสริมการหมักซึ่งจะทำาให้องค์ประกอบความ เป็นกรดด่างลดลง การกำาหนด ติดตาม และรักษาการ เปลี่ยนแปลงทางเคมี กายภาพ และจุล ชีววิทยาในผลิตภัณฑ์อาหารมีความสำาคัญ ต่อผู้ผลิตอาหาร เพราะเป็นสาเหตุหลัก ของการเสื่อมสภาพของอาหารที่ส่งผลต่อ อายุการเก็บรักษาของอาหารและขนมที่เรา โปรดปราน การทดสอบและวิเคราะห์อย่าง เหมาะสมเพื่อให้อาหารปลอดภัยจึงมีความ จำาเป็นเพิ่มมากขึ้น
จึงมีการใช้ขั้นตอนพิเศษระหว่าง
occur involving the internal food components and external environmental factors. These changes may cause food deterioration and reduce shelf life.
The most important chemical change is associated with enzymic action and oxidative reactions, particularly lipid oxidation that alters the flavor of food and non-enzymatic browning which causes changes in appearance.
At favorable temperatures, many enzymatic reactions proceed at a rapid rate altering the quality attributes of food. For example, fruit after cutting tend to brown rapidly at room temperature due to the reaction of phenolase with the cell constituents that are released upon cutting of the tissue in the presence of oxygen. Enzymes like lipoxygenase, if not denatured during the balancing process, can influence food quality even at sub-freezing temperatures. In addition to temperature, other environmental factors such as oxygen, water, and pH induce deleterious changes in food that are catalyzed by enzymes.
The presence of unsaturated fatty acids in foods is a prime reason for the development of rancidity during storage. The development of off-flavors may lead to other undesirable reactions including the loss of vitamins, alteration of color, and degradation of proteins.
The rate of lipid oxidation is influenced by several factors. Environmental temperature is an important variable. The presence of oxygen can increase the rate of oxidation as lipid oxidation occurs at a high rate with very low water activities. In determining the shelf life of foods
that contain lipids, the importance of their reaction mechanisms and their rates of reactions must be known.
In addition to lipid oxidation, other chemical reactions include light which cause the loss of vitamins and browning of meats. The influence of light on riboflavin loss in milk stored in a high-density polyethylene bottle.
Non-enzymatic browning is a major cause of quality change and degradation of nutrition content in many foods. This type of browning reaction occurs due to this interaction between reducing sugars and amino acids. These reactions result in the loss of protein solubility, darkening of colors, and the development of bitter flavors. Environmental factors such as temperature, water activity, and pH influence non-enzymatic browning.
Microbiological Changes
In determining the influence of microorganisms on the shelf life of foods, the rate of microbial growth as a function of various environmental factors must be known. Microbes can multiply and have generally good defense mechanisms against microbial attacks. However, after separation from the plant, they can easily succumb to microbial proliferation.
Similarly, meat upon slaughter is unable to resist rapidly growing microbes. Microbial growth in foods results in food spoilage with the development of undesirable sensory characteristics and in certain cases, the food may become unsafe for consumption.
The pathogenicity of certain microorganisms is a major food
safety concern in the processing and handling of food products. Upon ingestion, microorganisms such as Salmonella species and Escherichia coli strain may cause infection. Listeria monocytogenes, Campylobactor coli, Aspergillus flavus, Clostridium botulinum, and Staphylococcus aureus produce chemicals in foods that are toxic to humans.
The presence of molds and their growth on food products may result in undesirable appearance and off-flavors. Under certain conditions, mold spores may also produce chemicals that are toxic to humans. During food processing and storage, special procedures are employed to minimize or prevent the occurrence of pathogenic and spoilage microorganisms.
Various measures commonly used to minimize or prevent microbial growth in food include altering the environment temperature by either lowering the temperature to slow the growth processes or raising the temperature. Other approaches include removing water to stop microbes’ growth, controlling the environmental gases by lowering oxygen or increasing carbon dioxide concentration, adding acid, and promoting fermentation which will lower the pH composition.
Determining, monitoring, and keeping chemical, physical, and microbiological changes in food products are crucial for food manufacturers. Being the leading causes of food deterioration that affect the shelf life of our favorite food and snacks, there is a rising need to ensure proper testing and analysis are conducted to keep food safe.
39 Mar-Apr
Hong Kong Trade Development Council Facilitates the new collaboration of global healthcare with
Hong Kong International Medical and Healthcare Fair
Contact
ปิยฉัตร จิตเกษม Piyachat Chitkasem, Hong Kong Trade Development Council (HKTDC)
งานแสดงสินค้าด้านการแพทย์และการดูแลสุขภาพนานาชาติของฮ่องกง (Medical Fair) ครั้งที่ 14 จัดโดยองค์การ สภาพัฒนาการค้าฮ่องกง (HKTDC) และร่วมจัดโดยสมาคมอุตสาหกรรมอุปกรณ์การแพทย์และการดูแลสุขภาพ
โลกแห่งสุขภาพและความเป็นอยู่ที่
ของพาวิเลียนสมาคมอุตสาหกรรมอุปกรณ์การแพทย์และการดูแลสุขภาพฮ่องกง (HKMHDIA) และพาวิเลียนของ อุทยานวิทยาศาสตร์และเทคโนโลยีฮ่องกง (HKSTP)
Medical Fair
อุทยานวิทยาศาสตร์และเทคโนโลยีฮ่องกง (HKSTP) จัดพาวิเลียนขนาดใหญ่เพื่อจัด
จะจัดแสดงเทคโนโลยีและอุปกรณ์ทางการแพทย์ล่าสุด
ช่วยให้ผู้ที่อยู่ในอุตสาหกรรมมีความเข้าใจครอบคลุมเกี่ยว
รวมถึงช่วยให้พวกเขาสามารถจัดหาผลิตภัณฑ์และบริการล่าสุดอีกด้วย
และการลงทุนสำาหรับอุตสาหกรรมการดูแล สุขภาพในเอเชีย เพื่อสร้างเวทีด้านการดูแล สุขภาพที่ครอบคลุมเพื่อการแลกเปลี่ยนและ
40 www.innolabmagazine.com
ดึงดูดผู้จัดแสดงสินค้ามากกว่า 300 รายจากฮ่องกง แคนาดา จีนแผ่นดินใหญ่ ญี่ปุ่น ไต้หวัน และสหรัฐอเมริกา โดยหัวข้องานในครั้งนี้คือ “ปลดปล่อยพลังแห่งสุขภาพอัจฉริยะ” ประกอบด้วยโซนต่างๆ เช่น เทคโนโลยีชีวภาพ อุปกรณ์โรงพยาบาล การฟื้นฟูสมรรถภาพและการดูแลผู้สูงอายุ
ฮ่องกง (HKMHDIA)
ดี เวชภัณฑ์และวัสดุใช้แล้วทิ้ง และอุปกรณ์ห้องปฏิบัติการและโซนโซลูชันการผลิต พร้อมด้วยพื้นที่จัดแสดงนิทรรศการ
โซนต่างๆ
ผลิตภัณฑ์ทางการแพทย์และสุขภาพ และบริการที่เกี่ยวข้อง
กับเทรนด์ล่าสุดในอุตสาหกรรมการแพทย์
ATTRACTIONS
piyachat.chitkasem@hktdc.org +66 2 3439000 มหาวิทยาลัยได้กลายเป็นศูนย์กลางที่ สำาคัญสำาหรับการวิจัยและพัฒนาในสาขา เทคโนโลยีทางการแพทย์ (medtech) มหาวิทยาลัยในท้องถิ่น
งานด้าน R&D ที่เกี่ยวข้องกับอุตสาหกรรม การแพทย์และสุขภาพที่งาน
6 แห่งจะจัดแสดงผล
แสดงการพัฒนาทางเทคโนโลยีที่ล้ำาสมัย จากบริษัท 30 แห่ง รวมถึงบริษัทสตาร์ท อัพที่ HKSTP ดูแลอยู่ งาน Medical Fair จะประกอบด้วย กิจกรรมต่างๆ มากมายตลอดงาน รวม ถึงการประชุม HKMHDIA Medical Fair Forum ในวันแรกของงาน (16 พฤษภาคม) ซึ่งจัดโดย HKMHDIA ร่วมกับ HKTDC ภายใต้หัวข้อ “ฮ่องกงในฐานะศูนย์กลาง เทคโนโลยีทางการแพทย์นานาชาติ” การ ประชุมได้เชิญผู้เชี่ยวชาญในอุตสาหกรรมมา ประเมินข้อกำาหนดที่จำาเป็นสำาหรับการจัด ตั้งบริษัทเทคโนโลยีทางการแพทย์ในฮ่องกง และในโครงการเขตเศรษฐกิจพิเศษ (GBA) อีกทั้งจัดระบบนิเวศของเทคโนโลยีทางการ แพทย์ในทั้งสองที่ ครอบคลุมทุกอย่างตั้งแต่ กฎระเบียบที่เกี่ยวข้องและทรัพย์สินทาง ปัญญา ไปจนถึงการออกแบบผลิตภัณฑ์ การผลิต และความปลอดภัยทางไซเบอร์ บริษัทหลายแห่งจากต่างประเทศยังได้รับ เชิญให้มาแบ่งปันประสบการณ์ในการพัฒนา ธุรกิจด้านเทคโนโลยีทางการแพทย์อีกด้วย Medical Fair เป็นหนึ่งในกิจกรรมสำาคัญ ของสัปดาห์การดูแลสุขภาพนานาชาติครั้ง ที่สอง ขับเคลื่อนโดย HKTDC และจะจัด ขึ้นในวันที่ 16-31 พฤษภาคม 2566 งาน นี้จะใช้ประโยชน์จากบทบาทเชิงกลยุทธ์ ของฮ่องกงในฐานะศูนย์กลางนวัตกรรม
ความร่วมมือระหว่างผู้มีส่วนได้ส่วนเสียใน อุตสาหกรรมการดูแลสุขภาพทั่วโลก อีก หนึ่งกิจกรรมสำ า คัญของสัปดาห์การดูแล สุขภาพนานาชาติ คือ การประชุมสุดยอด เอเชียว่าด้วยสุขภาพโลก (ASGH) ครั้งที่ สาม ร่วมจัดโดยรัฐบาลเขตบริหารพิเศษ ฮ่องกง (HKSAR) และ HKTDC โดยจะจัด ขึ้นในวันที่ 17-18 พฤษภาคม งานวันแรก จะจัดขึ้นที่ศูนย์การประชุมและนิทรรศการ
(HKCEC) ขณะที่วันที่สองจะจัด แบบเสมือนจริงทั้งหมด
https://www.
asiasummitglobalhealth.com/ conference/asgh/en
https://internationalhealthcareweek. hktdc.com/en
งานแสดงสินค้าด้านการแพทย์และ
https://www.hktdc.com/event/ hkmedicalfair/en

https:// bit.ly/3VfXfMr
กิจกรรมต่างๆ: https://www. hktdc.com/event/hkmedicalfair/en/ intelligence-hub
• โปรแกรม: https://www. asiasummitglobalhealth.com/ conference/asgh/en/programme
• วิทยากร: https://www. asiasummitglobalhealth.com/ conference/asgh/en/speaker
The 14th HKTDC Hong Kong International Medical and Healthcare Fair (Medical Fair), organised by the Hong Kong Trade Development Council (HKTDC) and co-organised by the Hong Kong Medical and Healthcare Device Industries Association (HKMHDIA) has attracted more than 300 exhibitors from Hong Kong, Canada, Mainland China, Japan, Taiwan, and the US. Themed "Unleash the Power of Smart Health", the Fair will feature zones such as Biotechnology, Hospital Equipment, Rehabilitation and Elderly Care, World of Health & Wellness, Medical Supplies and Disposables and Laboratory Equipment & Manufacturing Solutions Zones, along with the exhibition areas of the Hong Kong Medical and Healthcare Device Industries Association (HKMHDIA) pavilion and the Hong Kong Science and Technology Parks (HKSTP) pavilion. The zones will showcase the latest medical technologies and equipment, medical and healthcare products, and related services, allowing industry players to get a comprehensive understanding of the latest trends in the medical industry as well as enabling them to source the latest products and services.
ฮ่องกง
เว็บไซต์ • สัปดาห์การดูแลสุขภาพนานาชาติ:
•
• รายการผลิตภัณฑ์ที่น่าสนใจ:
•
• การประชุมสุดยอดเอเชียว่า ด้วยสุขภาพโลก:
การดูแลสุขภาพนานาชาติของฮ่องกง:
เกี่ยวกับ HKTDC องค์การสภาพัฒนาการค้าฮ่องกง (HKTDC) เป็นองค์กรตามกฎหมายที่ก่อ ตั้งขึ้นในปี 2509 เพื่อส่งเสริม ช่วยเหลือ และพัฒนาการค้าของฮ่องกง ด้วยสำานักงาน 50 แห่งทั่วโลก ซึ่งรวมถึง 13 แห่งในจีน แผ่นดินใหญ่ HKTDC ส่งเสริมให้ฮ่องกง เป็นศูนย์กลางธุรกิจและการลงทุนทั่วโลก แบบสองทาง HKTDC เป็นผู้จัดนิทรรศการ นานาชาติ การประชุม และภารกิจทาง ธุรกิจ เพื่อสร้างโอกาสทางธุรกิจสำาหรับ บริษัทต่างๆ โดยเฉพาะธุรกิจขนาดกลาง และขนาดย่อมในตลาดแผ่นดินใหญ่และ ตลาดนานาชาติ HKTDC ยังมอบข้อมูล เชิงลึกของตลาดที่เป็นปัจจุบันและข้อมูล ผลิตภัณฑ์ผ่านทางรายงานการวิจัยและช่อง ข่าวดิจิทัล สำาหรับข้อมูลเพิ่มเติม กรุณาดู ที่เว็บไซต์ www.hktdc.com/aboutus และติดตามเราได้ที่ทวิตเตอร์ @hktdc และลิงด์อิน
Universities have become major hubs for research and development (R&D) in the medtech field. Six local universities will showcase R&D accomplishments relating to the medical and health industries at the Medical Fair. HKSTP is organising a sizeable pavilion where it will showcase cutting-edge technological developments from 30 corporations including start-up companies it has nurtured.
A variety of events will be held throughout the Medical Fair, including the HKMHDIA Medical Fair Forum organised by the HKMHDIA in strategic partnership with the HKTDC on the first day (16 May). Under the theme “Hong Kong as the International MedTech Hub”, the forum has invited industry experts to assess the essential requirements for setting up medical technology enterprises in Hong Kong and other GBA cities and unpack the medtech ecosystems in both places, covering everything from the relevant regulations and intellectual property to product design, manufacturing and cybersecurity. Several companies from overseas have also been invited to share their experiences in developing medtech businesses.
The Medical Fair is one of the flagship events of the second
International Healthcare Week, driven by the HKTDC and scheduled for 16 to 31 May 2023. The event will leverage Hong Kong's strategic role as an innovation and investment hub for the healthcare industry in Asia to build a comprehensive healthcare platform for exchanges and collaboration among stakeholders in the global healthcare industry. Another flagship event of the International Healthcare Week is the third Asia Summit on Global Health (ASGH), co-organised by the Government of the Hong Kong Special Administrative Region (HKSAR) and the HKTDC, which will take place on 17 and 18 May. The first day’s events will be held physically at the Hong Kong Convention and Exhibition Centre (HKCEC), while the second day will be entirely virtual.
Websites
• International Healthcare Week: https://internationalhealthcareweek. hktdc.com/en
• Hong Kong International Medical and Healthcare Fair: https://www. hktdc.com/event/hkmedicalfair/en
• Interesting Product List: https:// bit.ly/3VfXfMr
• Events: https://www.hktdc.com/ event/hkmedicalfair/en/intelligence-hub
Introduction and photos of some of the highlighted exhibits:
Robotic Wearable Exoskeleton

• Asia Summit On Global Health: https://www.asiasummitglobalhealth. com/conference/asgh/en
• Programme: https://www. asiasummitglobalhealth.com/ conference/asgh/en/programme
• Speakers: https://www. asiasummitglobalhealth.com/ conference/asgh/en/speaker
About HKTDC
The Hong Kong Trade Development Council (HKTDC) is a statutory body established in 1966 to promote, assist and develop Hong Kong's trade. With 50 offices globally, including 13 in Mainland China, the HKTDC promotes Hong Kong as a two-way global investment and business hub. The HKTDC organises international exhibitions, conferences and business missions to create business opportunities for companies, particularly small and medium-sized enterprises (SMEs), in the mainland and international markets. The HKTDC also provides up-to-date market insights and product information via research reports and digital news channels. For more information, please visit: www.hktdc. com/aboutus. Follow us on Twitter @hktdc and LinkedIn
EksoNR is a robotic exoskeleton specifically designed to be used in a rehabilitation setting to progress neurorehab patients so they can walk out of the device and back into their communities. As the first exoskeleton FDA-cleared for acquired brain injury, stroke, multiple sclerosis (MS) and spinal cord injury, EksoNR offers the industry’s most natural gait, reteaching the brain and muscles how to properly walk.
42 www.innolabmagazine.com
ข้อมูลเบื้องต้นและภาพของสิ่งจัดแสดงที่น่าสนใจบางส่วน:
EksoNR
EksoNR เป็นหุ่นยนต์ฝึกเดินเสมือนจริง ได้รับการออกแบบมาเป็นพิเศษเพื่อใช้ในการ ฟื้นฟูของผู้ป่วยโรคประสาท เพื่อให้พวกเขา สามารถหยุดใช้อุปกรณ์และกลับสู่สังคมได้
ได้รับการอนุมัติจากสำานักงานคณะกรรมการ อาหารและยาสำาหรับผู้ป่วยที่บาดเจ็บที่สมอง ผู้ป่วยโรคหลอดเลือดสมอง ผู้ป่วยโรคปลอก ประสาทเสื่อมแข็ง และผู้ป่วยที่บาดเจ็บ ที่ไขสันหลัง EksoNR มอบการเดินที่เป็น ธรรมชาติที่สุดในอุตสาหกรรม สอนสมอง และกล้ามเนื้อถึงวิธีการเดินที่ถูกต้องอีกครั้ง
ในฐานะหุ่นยนต์ฝึกเดินเสมือนจริงตัวแรกที่
Easyhear 5G Hearing Aid

Beamforming is instrumental to 5G superb performance in transmission speed and accuracy in mobile communication. EasyHear successfully applied this technology to hearing aid. Patented technology achieved 90% noise reduction that significantly upgraded speech clarity. Users could wear comfortably and listen clearly even in noisy environment
Portable positioning mechanism towards robotic needle intervention
ด้วยหุ่นยนต์ที่มีอยู่มักถูกจำากัดด้วยขนาดที่ใหญ่และความเข้ากันได้ไม่ดีกับ MRI จึงขาด สถานการณ์การใช้งานที่หลากหลาย
ตั้งแพลตฟอร์มการผ่าตัดด้วยหุ่นยนต์ได้อย่างมากและกำาหนดตำาแหน่งได้อย่างแม่นยำา ขณะที่เข้ากับ NMR
• This project developed a robotic needle surgery system for stereoscopic needle intervention procedures during surgery, including biopsy, drug delivery, stimulation, and more. Needle surgery systems that are manually led by surgeons often require high levels of surgeons' expertises and patient's condition, while being limited by lower precision and repetitive injuries from multiple needle insertions. Existing robotic surgical needle insertion systems, in turn, are often limited by their large size and poor MRI compatibility, thus lacking a wide range of application scenarios.
• The portable needle positioning robot developed in this project is portable, compact, and NMR-compatible. In practical experiments, it has greatly reduced the setup time of the robotic surgical platform and achieved accurate end-positioning, while having good NMR compatibility. These capabilities allow the robot to be rapidly deployed in response to different surgical situations and enable faster and safer surgical procedures, greatly reducing physician stress and patient suffering. The good MRI compatibility will allow the system to integrate multiple environmental information. With the help of artificial intelligence, the system can intermingle multiple information and obtain more powerful complex surgical processing capabilities.

43 Mar-Apr
• โครงการนี้พัฒนาระบบหุ่นยนต์เข็มผ่าตัดสำาหรับขั้นตอนการสอดเข็มแบบภาพสาม มิติระหว่างการผ่าตัด รวมถึงการตรวจชิ้นเนื้อ การให้ยา การกระตุ้น และอื่นๆ ระบบ การผ่าตัดด้วยเข็มที่ศัลยแพทย์ดำาเนินการด้วยตนเองมักต้องการความเชี่ยวชาญระดับ สูงของศัลยแพทย์และสภาวะของผู้ป่วย ขณะที่ถูกจำากัดด้วยความแม่นยำาที่ต่ำากว่าและ
ระบบการสอดเข็มผ่าตัด
• อย่างสะดวกหุ่นยนต์กำาหนดตำาแหน่งเข็มแบบพกพาที่พัฒนาขึ้นในโครงการนี้สามารถพกพาได้ กะทัดรัด และรองรับ NMR ในการทดลองจริงนั้น มันช่วยลดเวลาการติด
การบาดเจ็บซ้ำาๆ จากการสอดเข็มหลายครั้ง ในทางกลับกัน
ได้ดี ความสามารถเหล่านี้ทำาให้หุ่นยนต์สามารถถูกนำาไปใช้ได้อย่าง
รวดเร็วเพื่อตอบสนองต่อสถานการณ์การผ่าตัดที่แตกต่างกัน และทำาให้ขั้นตอนการผ่าตัดรวดเร็วและปลอดภัยยิ่งขึ้น ช่วยลดความเครียดของ แพทย์และความทุกข์ทรมานของผู้ป่วยได้อย่างมาก ความเข้ากันได้ดีกับ MRI จะช่วยให้ระบบสามารถผสานข้อมูลแวดล้อมต่างๆ เข้าด้วยกัน ด้วยความช่วยเหลือของปัญญาประดิษฐ์ ระบบสามารถรวมข้อมูลหลายอย่างเข้าด้วยกันและเสริมความสามารถให้ประมวลผลการผ่าตัดได้ซับ ซ้อนและทรงพลังยิ่งขึ้น
Beamforming มีประโยชน์สำาหรับ ประสิทธิภาพ 5G ที่ยอดเยี่ยมในด้าน ความเร็วในการส่งข้อมูลและความแม่นยำา ในการสื่อสารเคลื่อนที่ EasyHear ประสบ ความสำาเร็จในการประยุกต์ใช้เทคโนโลยี นี้เพื่อช่วยในการฟัง เทคโนโลยีจดสิทธิ บัตรนี้ช่วยลดเสียงรบกวนได้ถึง 90% ซึ่งช่วยให้เสียงพูดชัดเจนขึ้นอย่างมาก ผู้ ใช้งานสามารถสวมใส่ได้อย่างสบายและ ฟังได้อย่างชัดเจนแม้ในสภาพแวดล้อม ที่มีเสียงดัง
PROPAK ASIA 2023 CELEBRATES ITS 30TH ANNIVERSARY


Wantita Porntanawong, Marketing and Public Relations Specialist, Informa Markets Thailand Wantita.P@informa.com +66 2 0360518
Post-Harvest Innovation Tour:
ProPak Asia เองก็ยืนหยัดใน






Packaging Solutions: โพรเจกให้ คำ า ปรึกษาการออกแบบบรรจุภัณฑ์









จัดร่วมกันกับสมาคมการบรรจุภัณฑ์ไทย (Thai PDA) เพื่อยกระดับและพัฒนาผู้ ประกอบการในการบริหารจัดการเพื่อเพิ่ม ประสิทธิภาพ

44 www.innolabmagazine.com ในโอกาสครบรอบ 30 ปีของการจัดงาน ProPak Asia 2023 เราจึงตั้งใจมอบประสบการณ์พิเศษยิ่งกว่าครั้งไหน เพื่อเป็นส่วนหนึ่งในการยกระดับอุตสาหกรรมการผลิตและร่วมก้าวข้ามความท้าทายระดับโลก ด้วยวิถีทางแห่งความ ยั่งยืนและความรับผิดชอบต่อสังคม ATTRACTIONS
Contact วันทิตา พรธนาวงศ์
ในช่วง 30 ปีที่ผ่านมา อุตสาหกรรม การผลิตและบรรจุภัณฑ์มีพัฒนาการไป อย่างรวดเร็ว เกิดการเปลี่ยนแปลงอยู่ตลอด เวลา และจำาเป็นต้องปรับตัวให้ทันกับความ ต้องการในภาคการผลิต ซึ่งตลอดช่วงเวลา ดังกล่าว
การให้การสนับสนุนอุตสาหกรรมอย่างต่อ เนื่อง ด้วยการนำาเสนอโซลูชันทันสมัยและ เป็นเวทีเชื่อมโยงและเสริมสร้างเครือข่าย ธุรกิจให้เข้มแข็ง การผลิตให้เติบโตขึ้นอย่างรวดเร็วโดยหวังเร่งอุตสาหกรรม ในฐานะที่เป็นงานแสดงสินค้าเทคโนโลยี การผลิตและบรรจุภัณฑ์อันดับหนึ่งในเอเชีย ProPak Asia 2023 พร้อมตอกย้ำาความมุ่ง มั่นในการนำาเสนอประสบการณ์พิเศษสุดให้ กับอุตสาหกรรมการผลิตด้วยเทคโนโลยีล้ำา สมัยและกิจกรรมใหม่ๆ ภายในงาน ผู้คน ในแวดวงอุตสาหกรรมจากทั่วทุกมุมโลก ต่างตั้งตารอที่จะมาเข้าร่วมงานนี้ บนเนื้อที่ กว่า 42,000 ตารางเมตร ภายในฮอลล์ 98-104 ที่ต่างถูกจับจองจนเต็มพื้นที่แล้ว ซึ่งภายในงานยังมีพาวิเลียนนานาชาติจาก 11 ประเทศมาร่วมจัดแสดงด้วย ได้แก่ ออสเตรเลีย จีน ฝรั่งเศส เยอรมนี อิตาลี ญี่ปุ่น เกาหลี สิงคโปร์ ไต้หวัน สวิตเซอร์ แลนด์ และสหรัฐอเมริกา ในโอกาสครบรอบ 30 ปีครั้งนี้ ProPak Asia 2023 ได้ต่อยอดความสำาเร็จจากครั้ง ที่ผ่านมา โดยจัดแสดงโซลูชันหลากหลาย พร้อมทั้งไฮไลต์มากมายเพื่อให้ทันกับเทรนด์ ปัจจุบัน ได้แก่ ไฮไลต์ใหม่ของงาน
กิจกรรมนี้จัดร่วมกับสถานทูตเนเธอร์แลนด์ และคณะอุตสาหกรรมเกษตร มหาวิทยาลัย เกษตรศาสตร์ โดยจะนำ า เสนอเทคนิค สำาหรับจัดการผลิตผลทางการเกษตรหลัง การเก็บเกี่ยว ทั้งในด้านการป้องกัน เก็บ รักษา แปรรูป บรรจุ จัดส่ง ทำาการตลาด และนำาไปใช้งาน Lab Pavillion: กิจกรรมที่รวบรวม ข้อมูลแล็บและงานวิจัยสำาหรับผู้เชี่ยวชาญ งานวิจัยและพัฒนา รวมถึงนักวิเคราะห์ ข้อมูลเชิงคุณภาพโดยการเปรียบเทียบข้อมูล ไฮไลต์ต่อเนื่องจากปีที่ผ่านมา Sustainability Square: กิจกรรมนี้ จัดร่วมกันระหว่างมูลนิธิกระจกเงาและ วิสาหกิจชุมชนท่องเที่ยวเมืองสาปยา ซึ่งติด อันดับจุดหมายปลายทางสีเขียว (Green Destination 2022) 100 อันดับแรก จัด โดย Green Destinations Foundation Netherlands ซึ่งนำาเสนอด้วยสื่อเชิงโต้ตอบ ที่ผู้เยี่ยมชมหรือผู้แสดงสินค้าสามารถเรียน รู้เพิ่มเติมเกี่ยวกับความยั่งยืนได้
ซึ่ง
ลดต้นทุน และเพิ่มศักยภาพ เพื่อสมรรถนะที่ดียิ่งขึ้น
In celebration of its milestone 30th anniversary, ProPak Asia 2023 is set to be more special than ever to enhance the manufacturing industry and overcome global challenges in a sustainable and socially responsible way.
Over the last three decades, the Processing & Packaging industry has been developing quickly and adapting rapidly to manufacturing needs and ever-changing trends. ProPak Asia has stayed committed to offering key solutions, providing a solid support, and enabling businesses and professionals to connect and build strong networks with the common goal of accelerating the growth of the manufacturing industry.


As Asia’s number one processing and packaging technology event, ProPak Asia 2023 is ready to highlight its commitment to delivering a superior experience to the manufacturing industry with state-of-the-art technology and new features. Industrial professionals from around the world are eager to attend this event and over 42,000 sqm of Hall 98-104 has been fully occupied. There will be 11 international pavilions from countries such as Australia, China, France, Germany, Italy, Japan, Korea, Singapore, Taiwan, Switzerland, and the United States.
In honor of its 30th anniversary, ProPak Asia 2023 will continue to
build upon last year’s success by offering an even wider range of solutions as well as many highlights to meet current trends including:
New Highlight Features


Post-Harvest Innovation Tour: Co-hosted with the Embassy of the Netherlands and The Faculty of AgroIndustry from Kasetsart University, this event will address techniques applied to agricultural produce after harvest for its protection, conservation, processing, packaging, distribution, marketing, and utilization.
Lab Pavillion: Co-hosted with Innolab, this will gather research and lab information for research & development (RD) and qualitative comparative analysis (QCA) specialists.



Ongoing Highlight Features








Sustainability Square: Co-hosted with The Mirror foundation and Sapya Tourism Community enterprise, Top 100 Green destinations 2022 by Green Destinations Foundation Netherlands, this will be an interactive zone where visitors and exhibitors can learn more about sustainability.
Packaging Solutions: This consulting project for packaging design is co-hosted with the Thai Package Design Association (Thai PDA) to upgrade and develop entrepreneurs in management roles to increase productivity, reduce costs and enhance the potential for efficiency.
WPO Innovation stage: Co-hosted with The World Packaging Organisation (WPO), this will feature experts from around the world sharing insights on Sustainability in Packaging, Flexibility in Packaging and Food Safety through Packaging to help you and your business.

Future Food: A fully immersive experience co-hosted with TasteBud Lab where all your senses will experience the future of food, beverages, packaging and processing.
Do not miss the chance to join ProPak Asia 2023 and celebrate the 30th anniversary of this event and the growth of the Processing & Packaging industry as a whole. Discover all-new highlights at ProPak Asia 2023, which will be held from 14-17 June 2023 in Halls 98-104 at Bitec Bangna, Bangkok. Pre-registration at https:// www.propakasia.com

45 Mar-Apr
ทั่วโลกเพื่อแบ่งปันข้อมูลเกี่ยวกับบรรจุภัณฑ์ ทั้งในด้านความยั่งยืน ความยืดหยุ่น และ ความปลอดภัยอาหารที่เป็นประโยชน์กับผู้ ประกอบการและธุรกิจ Future Food: กิจกรรมนี้จัดร่วมกับ TasteBud Lab ซึ่งผู้เข้าร่วมจะได้ดื่มด่ำา ไปกับประสบการณ์แห่งอนาคตของอาหาร เครื่องดื่ม บรรจุภัณฑ์ และการแปรรูป ผ่าน ประสาทสัมผัสทั้งห้า อย่าพลาดโอกาสในการเข้าร่วมงาน ProPak Asia 2023 และก้าวย่างเข้าสู่ปี ที่ 30 ไปกับเรา พร้อมกับการเติบโตของ อุตสาหกรรมการผลิตและบรรจุภัณฑ์ไป ด้วยกัน แล้วท่านจะได้พบกับกิจกรรมน่า สนใจมากมายในงาน ซึ่งจะมีขึ้นระหว่าง วันที่ 14-17 มิถุนายน 2023 ในฮอลล์ 98-104 ณ ไบเทค บางนา ลงทะเบียนได้ที่ https://www.propakasia.com
WPO Innovation Stage: กิจกรรม นี้จัดร่วมกับองค์กรบรรจุภัณฑ์นานาชาติ
(WPO) โดยรวบรวมเอาผู้เชี่ยวชาญจาก
CPHI South East Asia 2023




Showcases Pharmaceutical Innovations







Arapong Tuntisereerat, Marketing Manager | FI Asia | CPHI | Vitafoods Asia, Informa Markets Thailand arapong.t@informa.com +6683 9454654
“ซีพีเอชไอ เซาท์อีส เอเชีย 2023” งานแสดงสินค้าเทคโนโลยีและนวัตกรรม ด้านเภสัชภัณฑ์ และผลิตภัณฑ์ด้านบรรจุ ภัณฑ์ พร้อมทั้งธุรกิจที่เกี่ยวเนื่องกับการ
ผลิตเภสัชภัณฑ์และบรรจุภัณฑ์ครบวงจร ระดับภูมิภาคเอเชียตะวันออกเฉียงใต้ จะ
46 www.innolabmagazine.com อินฟอร์มา มาร์เก็ตส์ ส่งเสริมอุตสาหกรรมยาและยาสมุนไพรในภูมิภาคเอเชียตะวันออกเฉียงใต้ จัดงาน “ซีพีเอชไอ เซาท์อีส เอเชีย 2023” (CPHI South East Asia 2023) ร่วมเกาะติดเทรนด์นวัตกรรมงานแสดงสินค้าเทคโนโลยีและ นวัตกรรม พร้อมการประชุมด้านวัตถุดิบ ส่วนผสม บรรจุภัณฑ์และเทคโนโลยีที่เกี่ยวเนื่องในการผลิตยา เปิดช่องทาง สร้างความร่วมมือทางธุรกิจ แนะไอเดียคนในแวดวงเภสัชกรรม เวชภัณฑ์ และนักลงทุน ร่วมยกระดับอุตสาหกรรม ยาไทย สร้างโอกาสครั้งใหญ่พาประเทศไทยก้าวสู่ศูนย์กลางด้านสุขภาพในยุค “สังคมสูงวัย” พร้อมส่งเสริมการ เป็นศูนย์กลางทางด้านสุขภาพของภูมิภาค เมกะเทรนด์ใหญ่ของโลก งานจัดระหว่างวันที่ 12-14 กรกฎาคม 2566 ฮอลล์ 1-3 ศูนย์ประชุมแห่งชาติสิริกิติ์ ATTRACTIONS
นางสาวรุ้งเพชร ชิตานุวัตร์ ผู้อำานวยการ กลุ่มงานภูมิภาคอาเซียน อินฟอร์มา มาร์เก็ตส์ ประเทศไทย เปิดเผยว่า ประเทศไทยเป็น หนึ่งในตลาดด้านเวชภัณฑ์หลักในภูมิภาค เอเชียตะวันออกเฉียงใต้ โดยในปี 2565 และ 2566 มีอัตราการเติบโต 3.5% ซึ่ง เป็นผลมาจากความกังวลที่เพิ่มขึ้นของชาว ไทยเกี่ยวกับสุขภาพ จากสัดส่วนประชากร สูงวัยที่เพิ่มขึ้น และปัจจัยกระตุ้นจากการ ระบาดของโรคโควิด-19 นอกจากนี้ยังพบว่า “ภาครัฐกำาหนดให้ อุตสาหกรรมยาเป็นหนึ่งในอุตสาหกรรมเป้า หมาย (new S-curve) ที่มีศักยภาพในการ สร้างมูลค่าเพิ่มให้แก่ประเทศ” ด้วยมูลค่า ตลาดยาในประเทศประมาณ 1.8 แสน ล้านบาท ซึ่งมีขนาดใหญ่เป็นลำาดับสองใน เอเชียตะวันออกเฉียงใต้ โดยเป็นรองเพียง อินโดนีเซียเท่านั้น ทั้งนี้ อินฟอร์มา มาร์เก็ตส์ ประเทศไทย ในฐานะผู้จัดงานที่ร่วมเป็นส่วนหนึ่งในการ ผลักดันอุตสาหกรรมยาของไทยให้สามารถ ก้าวสู่ผู้ผลิตยารายสำาคัญของโลกในอนาคต โดยขับเคลื่อนผ่านการจัดงาน “ซีพีเอชไอ เซาท์อีส เอเชีย 2023” ซึ่งจัดขึ้นเป็น ประจำาทุกปี และปีนี้ที่ประเทศไทยจัดยิ่ง ใหญ่ที่ศูนย์การประชุมแห่งชาติสิริกิติ์ มี Contact อาราพงษ์ ตันติเสรีรัตน์
พื้นที่รองรับการขยายตัวของอุตสาหกรรม ยากว่า 15,000 ตารางเมตร งานในปีนี้ มีความพิเศษในหลายส่วน ด้วยกัน ได้แก่ พาวิลเลียนนานาชาติ อาทิ จีน อินเดีย เกาหลี ยุโรป การนำาเสนอ ตัวเลือกทางการผลิตยาสมุนไพร การจัด แสดงนวัตกรรมด้านบรรจุภัณฑ์อัจฉริยะ การประชุมนานาชาติ และการสัมมนา ด้านเทคนิคสำาหรับอุตสาหกรรม พร้อม เทรนด์ต่างๆ ในด้านเภสัชกรรม การจับ คู่ทางธุรกิจ และกิจกรรมการตอบคำาถาม ทางด้านเภสัชศาสตร์ที่จะจัดเป็นครั้งแรก สำาหรับนักศึกษาทั่วประเทศภายในงานครั้งนี้ พร้อมกันนี้ ในงานได้นำ า เสนอยา สกัดสมุนไพร ยาที่ผลิตทางชีวเทคโนโลยี เวชภัณฑ์สำาหรับสัตว์ เพื่อเป็นการสนอง ตอบความต้องการของธุรกิจที่เกี่ยวกับ การผลิตยาใช้ในภูมิภาค และเป็นการส่ง เสริมให้ประเทศในภูมิภาคได้ร่วมสร้าง ความมั่นคงทางยา อีกความพิเศษภายใน งาน คือ การนำาเสนอโซลูชันด้านการจ้าง บุคคลภายนอก (outsourcing) บริการ ด้านการบริหารจัดการและการพัฒนาการ ทดลองทางคลินิก ฯลฯ ตลอดการจัดงาน 3 วัน ตั้งเป้าผู้เข้า ร่วมงานประมาณ 8,000 คน จาก 44 ประเทศ ได้แก่ ผู้ผลิตเวชภัณฑ์ระดับ ภูมิภาคและระดับนานาชาติ ที่กำาลังมอง หาส่วนประกอบต่างๆ บริษัทที่กำาลังหา พันธมิตรด้านการจัดจำาหน่าย ผู้จัดจำาหน่าย ในระดับภูมิภาคและระดับนานาชาติ
และการขายปลีก บริษัทที่ต้องการลงทุน ด้านชีววัตถุ การผลิตยาชีววัตถุคล้ายคลึง ในเอเชียตะวันออกเฉียงใต้และทั่วโลก
ผู้รับ จ้างผลิตตามสัญญาที่ต้องการเพิ่มกำาลังการ ผลิต Toll manufacturing ผู้เชี่ยวชาญ ด้าน Out-licensing การกระจายสินค้า
Informa Markets presents CPHI South East Asia 2023, a leading pharmaceutical solutions event, where a trade show on products, technologies, innovations, seminars on raw materials, pharmaceutical ingredients and packaging, technologies in pharmaceutical production, business matching, medical supplies, and much more, is to happen to promote pharmaceutical industry and herbal medicines in Southeast Asia. Investors and visitors will experience an event preparing Thailand as a medical hub for the upcoming aging society. CPHI South East Asia 2023 will take place during 12th-14th July 2023, at Hall 1-3, Queen Sirikit National Convention Center (QSNCC), Bangkok.

Rungphech Chitanuwat, Regional Portfolio Director – ASEAN Informa Markets-Thailand, revealed that Thailand was one of the leading pharmaceutical markets in Southeast Asia. Over 2022 and 2023, annual growth in the market should accelerate to 3.5% due to rising concerns among Thais over personal health and wellness, partly a side-effect of the Covid-19 pandemic and the aging of Thai society.
Furthermore, the government has determined the pharmaceutical industry as one of the “New S-curve” groups which could potentially create added value for the country. The domestic pharmaceutical market value at approximately 1.8 hundred billion Baht makes Thailand the second largest market in Southeast Asia after Indonesia.

Informa Markets Thailand, the organizer of this event, hopes that the annual CPHI South East Asia 2023 will promote the Thai pharmaceutical industry and that Thailand will become a leading pharmaceutical manufacturer in the future. This year, the event will be held at Queen Sirikit National Convention Center
(QSNCC) where more than 15,000 square meters will cater this ASEAN’s largest pharmaceutical event. Visitors and exhibitors alike will see pavilions from countries such as China, India, Korea, and European countries, presentations on options in herbal medicine productions, innovative packaging showcase, international conferences and technical seminars, and business matching. Plus, there will also be a Question-and-Answer session on pharmacy for university students, the first of its kind.
Many herbal-extracted products, medicines from biotechnology, and medical supplies for animals will be presented to meet the business demands on regional pharmaceutical productions and usages. It will also encourage the countries in this region to create medical stability. Other activities worth mentioning in this exhibition are outsourcing solutions, clinical trial development and management services, etc.
Throughout its 3-day event, CPHI South East Asia 2023 aims to welcome more than 8,000 participants from 44 countries including regional
and global pharma manufacturers looking for ingredients, companies looking for potential distribution partners, international and regional distributors, contract manufacturers looking for upscaling activities, Toll manufacturing, out-licensing specialist, distributors and retailers, etc.

CPHI South East Asia 2023, ASEAN’s leading pharmaceutical solutions event, will serve as starting point for new cooperations, data exchanges, and co-developments for private entities which will send a positive vibe to the overall economics. This exhibition will also promote good health to the people of Thailand and acts as a major step in the Thai pharmaceutical industry to become a pharmaceutical manufacturer. This will create medical stability in other countries in the region by ensuring that their people will have more access to medication.
Pre-registration in now available at https://www.cphi.com/sea.


47 Mar-Apr เป็นจุดเริ่มต้นของความร่วมมือใหม่ๆ
สนับสนุนให้เกิดสุขภาพที่ดีของผู้คนในประเทศ
ไทยในการพัฒนาและยกระดับศักยภาพเพื่อ
การ แลกเปลี่ยนข้อมูลและร่วมพัฒนาธุรกิจทั้ง ในระดับเอกชนที่ส่งผลดีต่อเศรษฐกิจ และ
นับเป็นอีกก้าวที่สำาคัญของอุตสาหกรรมยา
ก้าวสู่ผู้ผลิตยา
www.cphi.com/sea
สร้างความมั่นคงทางการยา
ให้กับประเทศต่างๆ
ในภูมิภาค โดยการนี้ จะส่งผลให้เกิดการเข้าถึงยาของประชาชน ในแต่ละประเทศได้มากขึ้นด้วย ลงทะเบียนชมงานได้แล้วที่ https://
Fi Asia Thailand 2023 launches the famed Asian’s f&b innovation industry event


Arapong Tuntisereerat, Marketing Manager | FI Asia | CPHI | Vitafoods Asia, Informa Markets Thailand arapong.t@informa.com +6683 9454654


Ms.Rungphech Chitanuwat, Regional Portfolio Director, Informa markets (Thailand), gave an opening speech at the “Food Ingredients Asia Forum” (Fi Asia Forum) under the concept of Holistic Perspective. consumers and approach to elevate integrated innovation Including analyzing the impact of the financial situation on the food and beverage industry by experts in the industry.
Including the country's leading professional associations and organizations such as Dr.Wisit Limlucha, President of the Thai Future Food Trade Association, Mr. Apirak Kosayodhin "Chairman of the Executive Committee, V Foods (Thailand), Ms. Kevalin Wangpichayasuk Deputy Managing Director of Kasikorn Research. Come and share their visions on adaptation in an era where consumer behavior is constantly changing. Strengthening innovation in food ingredients, beverages, for future food industries integrated that for a sustainable food system.
Together with Thai Future Food Trade Association, launched a new campaign called “Wen Day on Wednesday” in the Fi Asia Forum. To promote the consumption of future foods among Thai consumers and food service operators. Future foods from Thailand are now gaining traction with more varieties, superior taste, better nutrition and friendlier environmental practices. at the Queen Sirikit National Convention Center.
นิเวศน์ในอุตสาหกรรม (Eco-System) โดยครั้งนี้ได้ดึงผู้คร่ำาหวอดในวงการเพื่อจะนำาสิ่งที่เกิดขึ้นภายในงานฯ หยิบยกประเด็นขึ้นมา แล้วส่งเสริมผลักดันและสร้างเครือข่ายเพื่อให้เกิดกิจกรรมอย่างต่อ เนื่อง สู่เส้นทางไปยังงาน Food ingredients Asia (Fi







This FI Asia Forum is an initiative to look at food and beverage business development in Thailand. With an understanding of the entire ecosystem in the industry. By this time, it has drawn experienced people in the industry. To bring the issues raised to promote, create, and networking for ongoing activities in the Food ingredients Asia 2023 event (Fi Asia Thailand 2023) to be held in September 20-22 September 2023 at QSNCC.







48 www.innolabmagazine.com ATTRACTIONS
นางสาวรุ้งเพชร ชิตานุวัตร์ ผู้อำ า นวยการกลุ่มงาน ภูมิภาคอาเซียน อินฟอร์มา มาร์เก็ตส์ ประเทศไทย กล่าว เปิดงาน “Food Ingredient Asia Forum” (Fi Asia Forum) ภายใต้แนวคิด Holistic Perspective เผย เทรนด์ความต้องการในมุมมองผู้บริโภค แนวทางในการ ยกระดับนวัตกรรมแบบบูรณาการ รวมถึงวิเคราะห์ผล กระทบสถานการณ์เงินต่ออุตสาหกรรมอาหาร เครื่องดื่ม โดยมีผู้เชี่ยวชาญในอุตสาหกรรมฯ รวมถึงสถาบันการตลาด ชั้นนำาของประเทศ อาทิ ดร.วิศิษฐ์ ลิ้มลือชา นายกสมาคมการ ค้าอาหารอนาคตไทย คุณอภิรักษ์ โกษะโยธิน ประธานกรรมการ บริหาร บริษัท วี ฟู้ดส์ (ประเทศไทย) จำากัด คุณเกวลิน หวัง พิชญสุข ผู้ช่วยกรรมการผู้จัดการ บริษัท ศูนย์วิจัยกสิกรไทย จา กัด มาแชร์วิสัยทัศน์เรื่องการปรับตัวในยุคที่พฤติกรรมผู้บริโภคมี การเปลี่ยนแปลงอยู่ตลอดเวลา เสริมความแข็งแกร่งด้านนวัตกรรม ของอุตสาหกรรมส่วนผสมอาหาร เครื่องดื่ม และอาหารแห่งอนาคต แบบบูรณาการ เพื่อระบบอาหารที่ยั่งยืน พร้อมเปิดตัวแคมเปญใหม่ “เว้นเดย์ วัน Wednesday” ร่วมกับ 20 แบรนด์พันธมิตรเพื่อ รณรงค์ ประชาสัมพันธ์อาหารอนาคตให้เป็นที่รู้จักอย่างแพร่หลาย มากขึ้นต่อผู้บริโภค ตอกย้ำาการเป็นผู้สร้างรสชาติแห่งอาหาร ผ่าน งานส่วนผสมอาหารและเครื่องดื่ม ออชั้นนำาของโลก ณ ศูนย์การ ประชุมแห่งชาติสิริกิติ์ ชั้น 2 ห้องประชุม 211 การผนึกกำาลังร่วมกันจัดงานครั้งนี้ เพื่อเป็นการริเริ่มให้เกิด การมองการพัฒนาธุรกิจอาหารในประเทศไทยแบบเข้าใจทั้งระบบ
Asia Thailand 2023) จะจัดในเดือนกันยายน ระหว่างวันที่ 20-22 กันยายนนี้ ณ ศูนย์การประชุมแห่งชาติสิริกิติ์ Contact อาราพงษ์ ตันติเสรีรัตน์
PCHi 2023 Concludes with Record
Attendance in Guangzhou






Event Earns High Praise with Consistent Footfall










งาน PCHi ครบรอบ 15 ปีใน การให้บริการแก่อุตสาหกรรมการดูแลส่วน

49 Mar-Apr CATCH UP ในปีนี้
บุคคลทั่วโลก และถือว่าเป็นงานที่ประสบ ความสำาเร็จมากที่สุดอีกครั้งหนึ่ง โฆษก ของรี้ด ซิโนฟาร์ม เอ็กซิบิชั่นส์ (RSE) ให้ ความเห็นเกี่ยวกับการตอบสนองที่ดีจาก อุตสาหกรรมว่า “เราพอใจกับผลของงาน PCHi 2023 ทั้งในแง่ของเนื้อหา การจัด เตรียม หรือการมีส่วนร่วม การเข้าร่วมงาน อย่างล้นหลามและกิจกรรมที่เกิดขึ้นทั้งหมด ได้เพิ่มความเชื่อมั่นว่าอุตสาหกรรมกำาลัง จะฟื้นตัว อีกทั้งนวัตกรรมและการพัฒนา ผลิตภัณฑ์ใหม่จะเป็นหัวใจสำาคัญขณะที่ อุตสาหกรรมเติบโต” ความรู้สึกเชิงบวกปกคลุมไปทั่วบริเวณ ด้วยข้อจำากัดการเดินทางที่ถูกยกเลิก และความกระตือรือร้นโดยรวมที่จะกลับสู่ ‘ภาวะปกติ’ ทำาให้ผู้เชี่ยวชาญด้านการค้า มาปรากฏตัวเป็นจำานวนมากทั่วสถานที่จัด งานและห้องประชุม คลื่นมหาชนหลั่งไหล เข้ามาอย่างเห็นได้ชัดโดยเฉพาะในวันแรก และวันที่สอง แต่ความพลุกพล่านและเบียด เสียดยังคงดำาเนินต่อไปจนถึงคืนวันพฤหัสบดี “เราเลือกเปิดตัวสองผลิตภัณฑ์ที่งาน
และได้รับการตอบรับที่ดีมาก”
Jessica QU ผู้อำานวยการฝ่ายการ
PCHi 2023
Ms.
งานแสดงสินค้าด้านส่วนผสมเพื่อการดูแลบ้านและการดูแลส่วนบุคคล (PCHi) เวทีการจัดหาของจีนสำาหรับอุตสาหกรรม การดูแลส่วนบุคคลทั่วโลก ได้ปิดฉากลงแล้ว บริษัทผู้จัดแสดงสินค้ามากกว่า 700 แห่งและผู้เยี่ยมชมงานกว่า 30,000 คนเดิน ออกจากงานด้วยความพอใจอย่างยิ่งหลังสามวันเต็มของการค้นหาส่วนผสมและบริการใหม่ล่าสุด การสร้างเครือข่ายกับผู้มี อำานาจและผู้ขับเคลื่อนอุตสาหกรรม รวมถึงการเรียนรู้จากผู้คร่ำาหวอดในอุตสาหกรรม Author info เคลลี กวน Kelly Kuan Account Director, Red Bug Communications Pte Ltd kelly@redbugpr.com kelkuan
บุคคลของ Bloomage Biotechnology Corporation Limited กล่าว “ทีมงาน





ของเรามีงานล้นมือ และการพบกันในงาน


เมื่อถามถึงประสบการณ์ที่บริษัทได้รับ
ตลาดของ COSFA International Trading (Guangzhou) Co., Ltd. ให้ความเห็นว่า




การเข้าร่วมเกินความคาดหมายมาก
และการประยุกต์ใช้ของผู้ผลิตผลิตภัณฑ์
(PCHi Sustainability Zone) โฆษกของ RSE

ที่ลดผลกระทบด้านลบที่กิจกรรมทาง
และเรารู้สึกยินดี เป็นอย่างยิ่งที่ได้เห็นว่าส่วนนี้ของงานได้รับ


• การสัมมนาผ่านเว็บแบบไม่เสียค่า ใช้จ่าย (PCHi Webinars) ที่จะสำารวจ ตลาดความงามของจีนและหัวข้อต่างๆ ที่ มืออาชีพในภูมิภาคเอเชียแปซิฟิกให้ความ สนใจ
งาน PCHi ครั้งต่อไปจะจัดขึ้นระหว่างวัน ที่ 20-22 มีนาคม 2567 ณ ศูนย์นิทรรศการ และการประชุมเซี่ยงไฮ้
ตลาดสำาหรับส่วนผสมและโซลูชันการดูแลส่วน
สำาคัญเช่นนี้น่าตื่นเต้นมาก”
นั้น
Ms. Melly HUANG ผู้จัดการฝ่ายการ
เป็นโอกาสอันยอดเยี่ยม สำาหรับเราในการจัดแสดงผลิตภัณฑ์ล่าสุด ต่อผู้ชมทั่วโลก ฉันต้องบอกว่าผลลัพธ์จาก
และ เราจะติดตามผู้มุ่งหวังที่มีคุณภาพจากงาน นี้อย่างใกล้ชิด” ส่วนผสมนวัตกรรมที่สนับสนุนความ ยั่งยืนนั้นสามารถพบเห็นได้มากมายทั่วทั้ง ห้องจัดแสดงงาน แต่ที่สะดุดตาที่สุดคือ แนวคิดเรื่องการหมุนเวียน (circularity)
ดูแลส่วนบุคคล ซึ่งพบได้ในโซนความยั่งยืน
กล่าวว่า “เห็นได้ชัดว่าอุตสาหกรรม กำาลังดำาเนินไปในทิศทางที่ถูกต้อง ตอบ สนองความต้องการของผู้บริโภคในขณะ
แต่ ยังรวมถึงผู้คิดค้นสูตรด้วย
ซึ่งสามารถดึงความสนใจเพิ่มเติม
ผู้จัดแสดงงานที่ชนะรางวัลทำาการจัดแสดง ถ้วยรางวัลแก้วคริสตัลสีบานเย็นของตนเอง
เทรนด์ความงามของจีนกำาลังได้รับความ
หลายประเทศกำาลังติดตามการเปิดตัวส่วน ผสมล่าสุดและความต้องการของผู้บริโภค อย่างใกล้ชิด Ms. Olja RAKCEVIC ผู้ จัดการฝ่ายจัดซื้อของ Morning Sunlight Limited ซึ่งเป็นบริษัทการค้ากล่าวว่า “เรา ทำาการซื้อขายส่วนผสมที่หลากหลายและ ฉันมาที่นี่เพื่อหาส่วนผสมใหม่ๆ งานนี้ให้ ข้อมูลเชิงลึกที่มีค่ากับฉันเกี่ยวกับเทรนด์ และนวัตกรรมที่ร้อนแรงที่สุด ดังนั้น มันจึง เป็นการเยี่ยมชมที่ให้ผลดีพร้อมกับเนื้อหาที่ เกี่ยวข้องอีกมากมาย” งาน PCHi ที่กำาลังจะมาถึง
โลกยังมีอีกมากมาย ได้แก่: • การประชุมสุดยอดเทคโนโลยี (PCHi Technology Summit) ซึ่งจะจัดขึ้นที่ เซี่ยงไฮ้ในเดือนสิงหาคม 2566
“งาน PCHi 2023
อุตสาหกรรมมีต่อสิ่งแวดล้อม ผลิตเท่านั้นที่มีความตระหนักมากขึ้นไม่เพียงผู้
ความสนใจสูงมาก” อีกส่วนหนึ่งซึ่งใกล้กับทางเข้าหลักของงาน คือ งานประกาศรางวัล PCHi Fountain Awards
หลังการประกาศผลในเย็นวันแรกของงาน
อย่างเด่นชัด ซึ่งช่วยดึงดูดความสนใจของผู้ เข้าชมงานที่เดินผ่านบูทของพวกเขา
สนใจมากขึ้นในภูมิภาคอื่นของโลก และ
ในปีนี้ กิจกรรมภายใต้แบรนด์ PCHi สำาหรับอุตสาหกรรมการดูแลส่วนบุคคลทั่ว
เวิลด์ เอ็กซ์โป สำาหรับข้อมูลเพิ่มเติม โปรดเยี่ยมชม ที่เว็บไซต์ www.pchi-china.com/en หรือติดตามสื่อสังคมออนไลน์ของงาน PCHi
As the curtains fell on Personal Care and Homecare Ingredients (PCHi), China’s leading sourcing platform for the global personal care industry, more than 700 exhibiting companies and over 30,000 visitors departed the show grounds with a great sense of satisfaction after three full days of discovering the latest ingredients and service offerings, networking with industry movers and shakers, as well as learning from industry veterans.
This year marks PCHi’s 15th anniversary milestone of serving the global personal care industry, and it was one of the most successful editions of the show to date. Commenting on the industry’s positive response, a spokesperson from Reed Sinopharm Exhibitions (RSE) said, “We’re thrilled with how PCHi 2023 turned out, whether in terms of content, set-up, or engagement. The great attendance of the show and all our concurrent events has boosted industry confidence that rebound is imminent, and that innovation and new product development will take centrestage as the industry grows.”
All-round Positive Sentiments
With travel restrictions lifted and an overall eagerness to return to ‘normalcy’, trade professionals turned out in large numbers across the show floor and conference halls. The surge in attendance was evident, particularly on Day 1 and Day 2, but the hustle and bustle continued through till the end of Thursday.

“We chose to debut two products at PCHi 2023 and response has been overwhelmingly positive,” shared Ms. Jessica QU, Marketing Director for Personal Care Ingredients & Solutions at Bloomage Biotechnology
Corporation Limited. “Our team has been kept tremendously busy and there’s an excitement about gathering in-person at a significant event like this.”

When asked about her company’s experience, Ms. Melly HUANG, Marketing Manager at COSFA International Trading (Guangzhou) Co., Ltd., expressed, “PCHi 2023 was an excellent opportunity for us to showcase our latest products to a global audience. I’d say that the results from our participation far exceeded our initial expectations, and we’ll follow up closely with the quality leads we received at the show.”
Numerous innovative ingredients that support sustainability were spotted throughout the halls, but most notably, the concepts of circularity and how they are adapted by personal care manufacturers were explored in the PCHi Sustainability Zone. An RSE spokesperson said, “It’s evident that the industry is moving in the right direction, catering to consumer demands while minimizing the negative impact that industrial activities impose on the environment. There’s greater awareness not just with the manufacturers but also the formulators, and we’re very heartened to see a high level of interest in this segment of the show.”
Elsewhere near the venue’s main entrance, the PCHi Fountain Awards showcase drew additional attention after results were announced on the first evening of the event. Winning exhibitors made sure to prominently display their deep fuchsia crystal glass trophy, which in turn helped to attract the notice of visitors passing by their booths.
Chinese beauty trends are increasingly gaining interest in other


parts of the world and some are keeping a close watch on the latest ingredient launches and consumer demands. Ms. Olja RAKCEVIC, Procurement Manager at a trading company, Morning Sunlight Limited, said, “We deal in a wide spectrum of ingredients and I’m here to source. The show has provided me with valuable insights into the hottest trends and innovations, so it’s been a fruitful visit with plenty of relevant content.”
Upcoming PCHi Events
More PCHi-branded events are lined up this year for the global personal care industry, including:


• PCHi Technology Summit, to be held in Shanghai in August 2023

• A series of complimentary PCHi Webinars that explores the Chinese Beauty Market and various topics of interest to professionals in the Asia Pacific region
The next edition of PCHi is scheduled to take place from 20-22 March 2024 at the Shanghai World Expo Exhibition and Convention Center.
For more information, please visit www.pchi-china.com/en, or connect with PCHi on social media.
Mar-Apr
analytica Vietnam กลับมายืนหยัด

ความท้าทายล่าสุดที่อุตสาหกรรมต้องเผชิญ และผลการวิจัยที่นำาเสนอโดยผู้เชี่ยวชาญ ในอุตสาหกรรม ทัวร์ห้องปฏิบัติการก่อน เริ่มงาน การประชุมของผู้จัดแสดงสินค้า โปรแกรมผู้ซื้อ-ผู้ขาย ค่ำาคืนแห่งการสร้าง
ผู้เข้าร่วมงานได้รับโอกาสในการเรียนรู้ สร้างเครือข่าย และติดต่อกับผู้จัดแสดง สินค้า พาวิเลียนนานาชาติ และผู้นำาใน อุตสาหกรรมอีกครั้งโดยไม่มีค่าใช้จ่าย เนื่องจากเป็นการพบกันแบบตัวต่อตัว ครั้งแรกนับตั้งแต่ผลกระทบของโควิด-19 งาน analytica Vietnam 2023 ได้รับ การสนับสนุนจากยักษ์ใหญ่ในอุตสาหกรรม อย่างเทอร์โม ฟิชเชอร์, ไบโอเวีย (BIOVIA), และ BTG อีกทั้งยังนำาภาควิทยาศาสตร์และ
52 www.innolabmagazine.com CATCH UP Contact แดเนียล ชิ Daniel Shi Exhibition Director, MMI Asia Pte. Ltd. Daniel@mmiasia.com.sg Record-breaking success at analytica Vietnam 2023 งาน analytica Vietnam 2023 ทำาลายสถิติความสำาเร็จ การกลับ มาของกิจกรรมดึงดูดผู้เข้าชม งานและผู้เข้าร่วมงานมากที่สุดเป็น ประวัติการณ์ ปิดฉากด้วยผู้เข้าชม งานเพิ่มขึ้น 27% มีผู้ซื้อรวม 4,802 รายจาก 33 ประเทศเข้าร่วมงานใน ช่วง 3 วัน การประชุมมีผู้เข้าร่วม 582 คน บวกกับทัวร์ห้องปฏิบัติ การ และการประชุมเชิงปฏิบัติการ
ผู้เชี่ยวชาญด้านการวิเคราะห์ การวินิจฉัย ห้องปฏิบัติการ และเทคโนโลยีชีวภาพใน ตลาดเวียดนามและอาเซียน เมสเซ่ มึนเช่น ประกาศบทสรุปความ สำาเร็จของงาน analytica Vietnam 2023 งานแสดงสินค้านานาชาติชั้นนำ า สำ า หรับ เทคโนโลยีห้องปฏิบัติการ การวิเคราะห์ เทคโนโลยีชีวภาพ และการวินิจฉัยซึ่งจัด ขึ้นที่เวียดนามเมื่อสัปดาห์ที่แล้ว งานแสดง สินค้าและการประชุมครั้งนี้ดึงดูดผู้เชี่ยวชาญ ในอุตสาหกรรม 5,384 รายทั่วโลก ตลอด จนบริษัทและแบรนด์นานาชาติกว่า 200 แห่งเต็มพื้นที่จัดแสดงสินค้า ผลลัพธ์สะท้อน ให้เห็นว่างาน analytica Vietnam เป็น เวทีที่ดีที่สุดสำาหรับการแสดงความก้าวหน้า ล่าสุดในอุตสาหกรรมและส่งเสริมความร่วม มือระหว่างผู้ที่อยู่ในวงการ งานนี้ประสบ ความสำาเร็จอย่างไม่เคยมีมาก่อน ถือเป็น งาน analytica Vietnam ที่ใหญ่ที่สุด เท่าที่เคยมีมาด้วยพื้นที่จัดแสดงสินค้าเพิ่ม ขึ้น 10% พร้อมด้วยพาวิเลียนจากประเทศ เยอรมนี จีน สิงคโปร์ เกาหลี และเวียดนาม งานที่จัดขึ้นสามวันนี้ถือเป็นศูนย์กลาง ของกิจกรรม ประกอบด้วยการจัดแสดง เทคโนโลยีล่าสุด โปรแกรมการประชุม ระดับโลกที่มีการประชุมและการอภิปราย มากกว่า 30 หัวข้อ เน้นที่การแก้ปัญหา
ของผู้แสดงสินค้าภายในงาน
อีกครั้งในฐานะศูนย์รวมครบวงจรสำาหรับ
เครือข่าย และการเชิญผู้ซื้อรายใหญ่จาก ลาว กัมพูชา และเวียดนาม พิธีเปิดได้รับ เกียรติจากรัฐมนตรี คือ Bộ trưởng Huỳnh Thành Đạt และรัฐมนตรีช่วยว่าการ คือ Thứ trưởng Lê Xuân Định จากกระทรวง วิทยาศาสตร์และเทคโนโลยีของเวียดนาม
analytica Vietnam closes with an increase of 27% in visitor-ship, totalling 4802 unique buyers from 33 countries attending over the 3 days.

The event hosted 582 conference delegates, plus tailored laboratory tours, and exhibitor forum workshops on the show floor.
analytica Vietnam re-establishes its standing as the optimal onestop-shop for analysis, diagnostic, laboratory and biotech professionals in the Vietnam and ASEAN market.
Ho Chi Minh, Vietnam – April 19-21, 2023 – Messe München announces the successful conclusion of analytica Vietnam 2023, the premier international trade fair for laboratory technology, analysis, biotechnology, and diagnostics held in Vietnam last week. The tradeshow and congress all together drew in 5384 industry professionals globally as well as over 200 international companies and brands filling the exhibition hall. The results have conclusively reflected analytica Vietnam as the ultimate platform for showcasing the latest advancements in the industry and fostering meaningful collaborations among key players in the field. The event saw unprecedented success with the largest ever edition of analytica Vietnam, featuring a 10% increase in exhibition space, with country pavilions from Germany, China, Singapore, Korea and Vietnam.
The three-day event was a hub of activity, with exhibits showcasing the latest technologies, a world-class conference program featuring over 30 conference sessions and panel discussions focussing on solutions to the latest challenges facing the industry and research findings presented by industry experts, pre-event laboratory tours, exhibitor forum, buyer-seller
programs, networking nights, and hosted buyer delegations from Laos, Cambodia, and Vietnam. The event kicked off its Opening Ceremony with presence from Minister Bộ trưởng Huỳnh Thành Đạt and Vice Minister Thứ trưởng Lê Xuân Định from the Ministry of Science and Technology (MOST) in Vietnam. Attendees had the opportunity to learn, network, and reconnect with confirmed exhibitors, international pavilions, and key industry leaders, all free of charge.
As the first face-to-face meeting for the industry since the impact of COVID-19, analytica Vietnam 2023 welcomed sponsorship from industry giants such as Thermo Fisher, BIOVIA, and BTG, and brought together a spectacular reunion of the science and research sector.
The exhibition featured national and international industry leaders, including Thermo Fisher Scientific, Shimadzu, Merck, Leco, ITS, DKSH, 2H Instruments, Scilab, Eppendorf, and Waters. International exhibitors from countries such as Germany, Italy, UK, Japan, Canada, Korea, France, Czech Republic, USA, Singapore, India, Thailand, and China also showcased their latest innovations.
The German Federal Ministry for Economic Affairs and Climate Action and the Association of Small & Medium Enterprises Singapore (ASME) supported the exhibition with their respective pavilions. The exhibitors expressed satisfaction with the event with Sho-Wen Yeo, Vice President and General Manager, Southeast Asia & Taiwan of Thermo Fisher Scientific stating “Our key areas are biopharma, clean energy, food safety, and research innovations so the opportunities presented in analytica Vietnam 2023 very much align with what we are focusing on, which is a great match.”
“The success of analytica Vietnam 2023 exceeded our expectations, and we are thrilled to have welcomed leading professionals and companies from the laboratory technology, analysis, and biotechnology industries,” said Mr. Michael Wilton, CEO & Managing Director of MMI Asia Pte Ltd, organiser of the exhibition and a subsidiary of Messe München GmbH. “The event provided unparalleled opportunities for networking, learning, and discovering the latest products and technologies in the industry.”
The Vietnamese government and Messe München have been at the
54 www.innolabmagazine.com
forefront of industry development in Vietnam, and analytica Vietnam has been the perfect platform to support the further development of the industry in the country, facilitate know-how transfer, and promote investment in laboratory and biotechnology, according to Armin Wittmann, Project Director at Messe München GmbH.
As the organizer of analytica Vietnam, MMI Asia takes pride in hosting a successful event that facilitated knowledge exchange, networking, and business opportunities for all participants. The event provided a unique platform for stakeholders to connect, collaborate, and stay updated with the latest industry trends.

The impressive gathering at analytica Vietnam 2023 underscores the increasing demand for laboratory technology, analysis, and biotechnology solutions in the region, and the event has set the stage for further advancements in the industry. As the most significant gathering of professionals in Southeast Asia, analytica Vietnam continues to play a pivotal role in driving innovation, promoting investment, and facilitating knowledge exchange in the laboratory and biotechnology sectors. Plans are already underway for the next edition of analytica Vietnam, scheduled to be held on April 2-4 2025, at Saigon Exhibition and Convention Center in Ho Chi Minh, Vietnam, which is set to be even bigger and better, building on the success of this year’s event.
analytica Vietnam Main Conference
The analytica Vietnam Conference, took place parallel to the trade fair, featured over 30 conference lectures presented by national and international experts from the science and research sector across the globe. Topics covered included biomedical and forensic
analysis, novel analytical methods, food analysis, environment analysis, and quality control. The conference was organized by Prof. Dr. Oliver J. Schmitz from the University of Duisburg-Essen (Faculty of Chemistry) and Prof. Dr. Pham Hung Viet from VNU University of Science, KLATEFOS, as the program chairs. Highlights of the analytica Vietnam 2023 conference included insightful panel discussions that brought together industry leaders, researchers, and decision makers to discuss the latest trends, challenges, and opportunities in the laboratory technology, analysis, and biotechnology sectors. The panel discussions delved into topics such as digitalization and automation in laboratories, advancements in precision medicine, sustainable solutions for environmental analysis, and the future of biotechnology in Southeast Asia.
Laboratory Tours
The pre-event laboratory tours allowed attendees to visit leading laboratories and research facilities in Ho Chi Minh City and gain first-hand insights into cutting-edge technologies and best practices. Participants were able to personally witness and gain
the know-how into the procedure and technicalities of the laboratories in Vietnam, supported through the guided tour and allowing them to garner a deeper understanding of ASEAN research facilities.
Buyer-Seller Meeting Program
The buyer-seller programs went one step further to facilitate meaningful interactions between exhibitors and potential buyers, creating a conducive environment for business collaborations and partnerships. This edition saw the successful completion of 338 pre-arranged business meetings, reflecting a positive increasing trend from previous editions. On top of that, the networking nights and hosted buyer programs provided ample opportunities for participants to connect with fellow professionals, exchange ideas, and foster new business relationships. The event also witnessed the participation of high-level delegations from Laos, Cambodia and Vietnam, further enhancing regional cooperation and collaboration in the laboratory and biotechnology industries.
For more information, please visit: www.analyticavietnam.com.
55 Mar-Apr
ฟิชเชอร์ ไซเอนทิฟิคได้รับ การรับรอง ISO 17034 ทำาให้เป็นผู้ผลิต
(RM) ของ
ผลิตภัณฑ์ควบคุมคุณภาพวัสดุอ้างอิงที่ได้รับ
การรับรอง
(CRM) และ Thermo Scientific™ Quanti-Cult Plus™

การอัปเดตเอกสารเพื่อแสดงกระบวนการ ผลิตและการทดสอบผลิตภัณฑ์ที่มีการ ควบคุม การประเมินการตรวจสอบย้อน กลับทางมาตรวิทยาและการวัดความไม่ แน่นอน และการปรับปรุงกระบวนการผลิต เคลลี แบล็ก ประธานบริษัท Neptune and Company, Inc. ทำางานร่วมกับ เทอร์โม ฟิชเชอร์ ไซเอนทิฟิคอย่างใกล้ชิด ตลอดกระบวนการรับรองมาตรฐาน ISO ที่ ยาวนาน เธอเป็นประธานของคณะกรรมการ
และเป็นคณะกรรมการที่ ปรึกษาด้านเทคนิคผู้ผลิตวัสดุอ้างอิงของ A2LA และเป็นสมาชิกของ ISO TC 334 (วัสดุอ้างอิง) เคลลี แบล็ก กล่าวว่า “ห้อง ปฏิบัติการทุกแห่งที่ดำาเนินกิจกรรมการวัด จำาเป็นต้องมีวัสดุอ้างอิงเพื่อให้มั่นใจในความ เที่ยงตรง ความแม่นยำา และความถูกต้อง
ของการวัด ยิ่งมีการใช้วัสดุจากผู้ผลิตวัสดุ อ้างอิงที่ได้รับการรับรองบ่อยเท่าไร ห้อง ปฏิบัติการจะเสี่ยงต่อการวัดผิดพลาดน้อย ลงเท่านั้น โรงงานที่ใช้วัสดุคุณภาพสูงเหล่า นี้จะมีความเสี่ยงเรื่องข้อผิดพลาดในห้อง ปฏิบัติการหรือการผลิตน้อยลง”
56 www.innolabmagazine.com NEWS ISO 17034 รับรองวัสดุอ้างอิง ที่เชื่อถือได้ หนึ่งในผลิตภัณฑ์ด้านจุลชีววิทยา ของเทอร์โม ฟิชเชอร์ ไซเอนทิฟิค ได้รับ การรับรองมาตรฐาน ISO 17034 ซึ่งรับ ประกันถึงคุณภาพ วัสดุอ้างอิงที่สอดคล้อง กัน การปฏิบัติตามกฎระเบียบ และความ มั่นใจในผลลัพธ์ เมืองเลเนซา รัฐแคนซัส สหรัฐอเมริกา – ในฐานะส่วนหนึ่งของแรงขับเคลื่อนเพื่อ การปรับปรุงอย่างต่อเนื่อง จุลชีววิทยา ของเทอร์โม
วัสดุอ้างอิงที่ได้รับการอนุญาต
(CRM) หลังจากการประเมิน และการตรวจสอบอย่างครอบคลุม สมาคม อเมริกันสำาหรับการรับรองห้องปฏิบัติการ (A2LA) ออกหมายเลขใบรับรอง 6559.01 ให้ในเดือนพฤศจิกายน 2565 ข่าวดังกล่าว ทำาให้ลูกค้าของเทอร์โม ฟิชเชอร์ ไซเอนทิฟิค มีความมั่นใจในผลิตภัณฑ์ควบคุมคุณภาพ และการปฏิบัติตามกฎระเบียบของพวกเขา เพิ่มมากขึ้น การรับรองนี้ประยุกต์ใช้กับกลุ่มสิ่งมี ชีวิตที่ต้องควบคุมคุณภาพ หมายความว่า Thermo Scientific™ Culti-Loops™ ซึ่ง เป็นสิ่งมีชีวิตที่ต้องควบคุมคุณภาพเชิงคุณภาพ มากกว่า 400 ชนิดมีสถานะวัสดุอ้างอิงที่ ได้รับการรับรอง
ซึ่ง เป็นสิ่งมีชีวิตที่ต้องควบคุมคุณภาพเชิง ปริมาณ
ชนิดมีสถานะวัสดุอ้างอิงที่ได้ รับการอนุญาต (RM) การควบคุมคุณภาพเป็นสิ่งสำ า คัญใน การรักษาความแม่นยำาและประสิทธิภาพ โดยไม่คำานึงถึงความผันแปรอย่างการปรับ เปลี่ยนวิธีการหรือการเพิ่มขนาดตัวอย่าง การเลือกผลิตภัณฑ์จากผู้ผลิตที่ได้รับการ รับรองมาตรฐาน ISO 17034 รับประกัน ถึงผลิตภัณฑ์ควบคุมคุณภาพที่มีคุณภาพสูง ซึ่งยังรวมไปถึงกระบวนการควบคุมคุณภาพ ด้วย การรับรองคุณภาพยังหมายความว่า ผลิตภัณฑ์เป็นไปตามกฎระเบียบ มาตรฐาน และแนวปฏิบัติสากลด้านเภสัชกรรม คลินิก และอุตสาหกรรม ซึ่งรวมถึง ISO 15189 และ ISO 17025 ตลอดจนมาตรฐานตำารับ ยาต่างๆ แนวปฏิบัติสากลขององค์การ อนามัยโลก (WHO) องค์การอาหารและ ยาแห่งสหรัฐอเมริกา (FDA) และ AOAC ต่างแนะนำ าให้ใช้วัสดุอ้างอิงการควบคุม คุณภาพจากซัพพลายเออร์ที่ได้รับการรับรอง มาตรฐาน ISO 17034 เพื่อให้ได้รับการรับรอง เทอร์โม ฟิช เชอร์ ไซเอนทิฟิคเริ่มดำาเนินการปรับปรุง อย่างต่อเนื่องในโครงการสามปี ซึ่งรวมถึง
25
วิชาการไอเอสโอ
การทางสถิติ)
69 (การประยุกต์ใช้วิธี
คุณภาพ Thermo Scientific™ CultiLoops ™ มอบเชื้อมาตรฐานสำาหรับการ
Accreditation (A2LA) in November 2022 after a comprehensive evaluation and audit. The news provides Thermo Fisher Scientific’s customers with an additional level of confidence in their QC products and in their regulatory compliance.
ATCC® และการเพาะเชื้อ NCTC สิ่งมีชีวิตที่ต้องควบคุมคุณภาพเชิงปริมาณ Quanti-Cult Plus เป็นจุลินทรีย์บรรจุฟิล์ม ภายในฝาขวดพลาสติก เมทริกซ์ซึ่งมอบการ ตรวจสอบย้อนกลับอย่างสมบูรณ์แก่อนุพันธ์ที่ ได้รับอนุญาตของ ATCC
The certification applies to the portfolio of quality control (QC) organisms. It means more than 400 Thermo Scientific™ CultiLoops™ qualitative QC organisms have CRM status, and 25 Thermo Scientific™ Quanti-Cult Plus™ quantitative QC organisms have accredited RM status.
qualitycontrol
ISO 17034 CERTIFICATION ASSURES RELIABLE REFERENCE MATERIALS
Thermo Fisher Scientific Microbiology’s ISO 17034 accreditation assures high quality, consistent reference materials, regulatory compliance, and confidence in results.
LENEXA, KANSAS U.S. – As part of its drive for continual improvement, Thermo Fisher Scientific Microbiology has achieved International Organization for Standardization (ISO) 17034 certification, making it an accredited reference material (RM) manufacturer of certified reference material (CRM) quality control products. Accreditation certificate number 6559.01 was granted by the American Association for Laboratory
Quality control is essential in maintaining high levels of accuracy and proficiency regardless of variabilities such as changing methods or increasing sample sizes. Choosing products from an ISO 17034 accredited manufacturer assures high quality QC products and, by extension, QC processes. Accreditation also means product compliance with global regulations, standards, and guidelines covering pharmaceutical, clinical, and industrial settings. These include ISO 15189 and ISO 17025, as well as various Pharmacopoeia standards. World Health Organization (WHO), US Food and Drug Administration (FDA), and AOAC International guidelines all recommend the use of quality control reference materials from an ISO 17034 accredited supplier.
To achieve certification, Thermo Fisher Scientific embarked on a threeyear program of continual improvement that included: updating documentation to demonstrate controlled manufacturing and testing processes for products, evaluating metrological traceability and measurements of uncertainty, and improving production processes.
Kelly Black, President of Neptune and Company, Incorporated, worked closely with Thermo Fisher Scientific throughout the lengthy ISO accreditation process. She is the Chair of the ISO Technical
Committee (TC) 69 (Applications of Statistical Methods) and the A2LA Reference Material Producer Technical Advisory Committee, and a member of ISO TC 334 (Reference Materials). Kelly Black stated, “All laboratories that conduct any type of measurement activities need RMs to ensure the validity, precision, and accuracy of their measurements. The more frequently materials from an accredited RM producer are used, the less risk laboratories have of false measurements. Facilities that make use of these high-quality materials will be at a reduced risk of laboratory or production errors.”
The accreditation applies to the QC organisms portfolio:
Thermo Scientific™ Culti-Loops™ qualitative QC organisms provide standardized cultures for quality control testing that can be prepared quickly, easily, and safely. These ready-to-use, disposable bacteriological loops contain stabilized viable microorganisms, and offer complete traceability to ATCC® Licensed Derivative and NCTC cultures. Quanti-Cult Plus quantitative QC organisms are supplied as a film of preserved microorganisms inside the cap of a plastic vial. The matrix, which offers complete traceability to ATCC® Licensed Derivative and NCTC cultures, is ready for rehydration and use in QC procedures,
Ultimately, robust and compliant microbiological QC processes rest on a foundation of quality materials and that foundation is assured by ISO 17034 accreditation.
For more information on the complete range of quality control solutions, visit thermofisher.com/qualitycontrol. News info
Thermo Fisher Scientific - March 16, 2023
57 Mar-Apr การรับรองคุณภาพประยุกต์ใช้กับสิ่ง
สิ่งมีชีวิตที่ต้องควบคุมคุณภาพเชิง
ทดสอบการควบคุมคุณภาพ
จัดเตรียมได้อย่างรวดเร็ว ง่ายดาย และ ปลอดภัย ห่วงเขี่ยเชื้อแบคทีเรียพร้อมใช้ แบบใช้แล้วทิ้งประกอบด้วยจุลินทรีย์มีชีวิต ที่เสถียร และมอบการตรวจสอบย้อนกลับ อย่างสมบูรณ์แก่อนุพันธ์ที่ได้รับอนุญาตของ
®และการเพาะเชื้อ NCTC พร้อมสำาหรับการคืนสภาพและนำา ไปใช้ในขั้นตอนการควบคุมคุณภาพ ท้ายที่สุด กระบวนการควบคุมคุณภาพ ทางจุลชีววิทยาที่แข็งแกร่งและเป็นไปตาม ข้อกำ า หนด อาศัยรากฐานของวัสดุที่มี คุณภาพ และรากฐานดังกล่าวได้รับการ รับรองมาตรฐาน ISO 17034 สำาหรับข้อมูลเพิ่มเติมเกี่ยวกับโซลูชัน
มีชีวิตที่ต้องควบคุมคุณภาพ:
ซึ่งสามารถ
การควบคุมคุณภาพที่ครบถ้วนสมบูรณ์ สามารถศึกษาได้ที่
thermofisher.com/
Your subscription
Fill out your detail or attach your business card
Subscription Date .................................................................................. Where did you find us? ................................................................................ Your name Your job title Your e-mail Your mobile number ....................................................................................... Company name Company address Country ......................................... Zip code ........................................ Website Tel no. ........................................... Fax no. .......................................... Name and address on receipt □ Same as above □ Other, please specify Your industry (please select your interest by inputting ü) □ Food/Beverage □ Supplements/Nutraceuticals □ Cosmetics □ Pharmaceuticals/Medicals □ Environment □ Energy □ Other, please specify ................................................................................ Your business (please select your interest by inputting ü) □ Manufacturer □ Distributor □ Certification body □ Laboratory service □ Academics □ Government body □ Consultancy □ Other, please specify .............................................. Your job function (please select your interest by inputting ü) □ Management □ Purchasing □ Sales/Marketing □ QC/QA □ QMR/Document Control □ R&D □ Chemist □ Microbiologist □ Production □ Consultant □ Other, please specify .............................................................................................. Your interest (please select your interest by inputting ü) □ Ingredients □ Additives □ Chemicals □ Reagents □ Methods □ Techniques □ Instruments □ Equipment □ Tools □ Softwares □ Lab Facilities □ Lab Design □ Laws/Regulations □ Standards □ Interview □ Industry/Market trend □ Other, please specify ..............................................................................................
engagement (please rank the score 1-5, 5 = most engaged) Enhancing work capability Seeking products & services Finding out industry movement _ Joining INNOLAB’s activities, seminar and conferences _ Other, please specify .........................................................................................
Your
communication channel
_ E-mail _ Post mail _ Fax _ Facebook, www.facebook.com/innolabmagazine Other, please specify ..............................................................................................
interest seminar topic Your suggestion
Domestic reader □ 1-year 900 THB Oversea reader □ 1-year 90 USD □ 2-year 1500 THB □ 2-year 170 USD
remit payment to MEDIA MATTER Co., Ltd., savings account number 1082280729, Siam Commercial Bank Pcl.
+66 2878 1026 or innolab@media-matter.com
Your preferred
(please rank the score 1-5, 5 = most convenient)
Your
Please
The swift code is SICOTHBK. Please send the pay-in slip via fax number
SUBSCRIPTION FORM
บริษัท มีเดีย แมทเทอร์ จำ า กัด 43/308 หมู่ 1 ถนนจอมทอง แขวงจอมทอง เขตจอมทอง กรุงเทพฯ 10150 MEDIA MATTER Co., Ltd. 43/308 Moo 1, Jomthong Road, Jomthong, Bangkok 10150 Thailand TaxID 0105552007301 Tel +66 875171651 International Call +66 945530616 Fax +662 045 5358 innolab@media-matter.com WWW.INNOLABMAGAZINE.COM